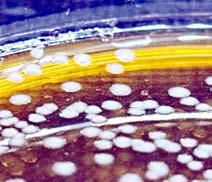

![]()






By
ASHAKY ceasefire between Iran and Israel took effect yesterday, with both sides violating the truce hours after it took effect.
US President Donald Trump on Monday evening (Tuesday morning, Manila time) said the ceasefire would bring about an “official end” to the 12day conflict.
"It has been fully agreed by and between Israel and Iran that there will be a Complete and Total CEASEFIRE," Trump wrote on his Truth Social platform.
By late afternoon, an angry Trump berated Iran and Israel for violating the ceasefire deal, adding that he was "really unhappy" with Israel in particular.
The two countries have been "fighting so long and so hard that they don't know what the f*ck they're doing, do you understand that?" the US president told reporters at the White House.
Israeli Defense Minister Israel Katz said Tuesday he had ordered the army "to respond forcefully to Iran's violation of the ceasefire" after incoming
ICC prosecutors reject interim release for Rody
By Pot Chavez and
Superable







RECORD
DRUG HAUL. President
Ferdinand Marcos points to the record shabu haul valued at P8.8 billion pesos recovered in Pangasinan Bay which were displayed during his inspection yesterday at the headquarters of the Philippine Drug Enforcement Agency (PDEA). With the President are Sec. Oscar F. Valenzuela of the Dangerous Drugs Board, DILG Sec. Jonvic Remulla, Usec. Isagani Nerez, PDEA Director General, Pnp Chief Nicolas Torre and PDEA Asec. Renato Gumban. Revoli Cortez/PPA POOL
By Charles Dantes, Alena Mae Flores, Vito Barcelo, Joel Zurbano and Rex Espiritu
AMID the volatile ceasefire between Israel and Iran, the government is still preparing for the repatriation of Filipinos
By Charles Dantes
MALACANANG on Tuesday dis-
missed Vice President Sara Duterte’s criticism of the Marcos administration’s foreign policy, particularly its decision to allow foreign missile systems in the country. In a briefing at the Palace, Presidential Communications Office Undersecretary Claire Castro retorted to the Vice President’s recent remarks,
questioning the rationally of permit-
who wish to return to the Philippines as well as for the timely rollout of fuel subsidies to PUV drivers, farmers and fisherfolk should the average price of crude oil breach the $80 per barrel threshold.
"The hope is that the ceasefire lasts longer," Department of Energy officerin-charge Sharon Garin said, adding that fewer countries seem likely to be
drawn into the conflict.
"For now, the sentiment is one of cautious optimism. If the conflict doesn’t worsen, we expect the economic impact to remain manageable," she added.
Domestic pump prices are expected to decline following the announcement of a ceasefire, Jetti Pe-
troleum president Leo Bellas, noting that prices fell sharply in early Asian trading.
“a this trend continue, we could see prices making an abrupt U-turn to easing down,” Bellas said.
If solely based on Monday’s Mean of Platts Singapore pricing, the projected
ting a foreign power, believed to be the United States, to deploy missile systems in the Philippines.
"The President said we expect that from the Dutertes because they are pro-China. The President is pro-Philippines," Castro said.
Duterte had warned against antagonizing rival powers. “You allow missiles from a foreign power into your country, knowing they are hated by that country's enemies.”
HOME SAFE. All 31 overseas Filipino workers (OFWs) repatriated from Israel, Jordan, Palestine, and Qatar are welcomed upon their arrival in Manila. Their departure from Doha, Qatar was delayed due to the temporary closure of Qatari airspace following an Iranian missile attack on a US air base in the Gulf state. DMW






By Rex Espiritu
THE Japanese government is eyeing deeper bilateral security and defense collaboration with the Philippines through the recently ratified Reciprocal Access Agreement (RAA).
‘‘The RAA is a legal framework that contributes to taking national security and defense cooperation to a higher level. It will also facilitate joint training and other cooperative activities between units of both
countries and enhance interoperability,’’ Japanese Ambassador to the Philippines Endo Kazuya said in an interview Monday evening.
Earlier this month, Japan’s Diet ratified the landmark defense pact, paving the way for enhanced cooperation. The RAA provides a legal foundation allowing troops from both nations to enter each other’s territory for joint military exercises and other activities.
By Maricel V. Cruz
on
From A1
Iranian missiles were reported by the military.
"I instructed the Israeli army to respond forcefully to Iran's violation of the ceasefire by launching powerful strikes against regime targets in the heart of Tehran," Katz said in a statement.
Iran's armed forces, on the other hand, accused Israel of launching strikes at the Islamic republic until Tuesday morning.
"The Zionist regime launched three waves of attacks on sites in Iranian territory until 9:00 am (0530 GMT) today," a spokesman for the armed forces command was quoted as saying
PH...
From A1
movement on domestic pump prices
ranges from P0.75 to P0.95 and P1.45 to P1.65 on diesel and gasoline, respectively.
Despite the easing of oil prices, Garin said the government is coordinating with relevant agencies to finalize the distribution of the subsidy programs following President Ferdinand Marcos Jr.’s meeting with his economic team.
“We also have an ongoing meeting with DOTr (Department of Transportation) and DA (Department of Agriculture) and LTFRB (Land Transportation
of Duterte was necessary to ensure his appearance at the trial.
They argued that the former president does not recognize the legitimacy of the legal proceedings against him, claiming that he was abducted by the ICC.
The prosecutors also cited Duterte's political position and international contacts which are "relevant factors in determining the risk of flight and may contribute to their ability to abscond."
Likewise, his financial situation and resources can also be a factor relating to his family’s powerful position and connections, the prosecutors noted.
They also contended that Duterte's continued detention was imperative to ensure that he does not obstruct or endanger the investigation or court proceedings, underscoring that his associates have a history of interfering with investigations against him.
"If released, [Duterte] would have greater access to his associates and family who remain in positions of power
From A1
‘‘This is a big win for ordinary Filipinos,’’ Romualdez said. ‘‘This is the result of the cooperation of Congress, PhilHealth, and the entire government.’’
The Speaker has consistently pushed for reforms in the national health insurance system to address the actual needs of patients and their families. He said the new PhilHealth benefits directly respond to long-standing concerns raised by the House of Representatives during hearings, consultations, and dialogues with stakeholders. One of the most urgent improve-
Japan...
From A1
‘‘As the specific plans for our cooperation will need to be discussed following the ratification of the RAA, I would like to refrain from giving details at this stage,’’ Kazuya said. ‘‘But in any case, Japan hopes to further strengthen security and defense cooperation between Japan and the Philippines through training and other activities between the two countries forces.’’
The agreement was signed on July 8, 2024, following negotiations centered on shared security interests, freedom of navigation, and humani-
on state TV, without providing further details.
Despite the volatile ceasefire, oil prices sank 3.5 percent and shares in Asia were buoyant as fears of an energy market shock eased.
"Tehran played it cool. Their 'retaliation' hit a US base in Qatar – loud enough for headlines, quiet enough not to shake the oil market's foundations," said Stephen Innes at SPI Asset Management.
"And once that became clear, the war premium came crashing out of crude."
EU chief Ursula von der Leyen on Tuesday said that the continent "welcomes" the ceasefire announcement.
"It's an important step towards restoring stability in a region in tension. This must be our collective priority,"
Franchising and Regulatory Board) to make sure that whatever happens, whether it happens, if it happens, we are ready to distribute the subsidies to our PUV drivers, operators, our farmers and fisherfolk,” Garin said in a press briefing in Malacañang.
Garin said a total of P2.5 billion has been earmarked for PUV drivers and operators, while P600 million is allocated for farmers and fisherfolk.
The DOTr has already completed the identification of beneficiaries and is prepared to release the funds as soon as it receives the go-signal, Garin said, adding that coordination with banks and logistical arrangements are still
with access to networks and personnel to carry out witness interference," the prosecution’s document read.
Meanwhile, Duterte is looking at Australia as one of the countries for his possible interim release, according to his daughter Vice President Sara Duterte.
The Vice President made the confirmation over the weekend while on a personal trip in Australia.
“Australia is in the list of countries that are considered by the lawyers, but I am not here for the interim release. Not for this visit,” VP Sara said in an ambush interview.
She said that she went to Australia because she wanted to bring to the international community and talk to the Filipino community there “about the International Criminal Court and the case of former President Duterte [and discuss] what is happening in our country right now in terms of the performance of the administration of President Marcos.”
She also said that she tried to reach out to Australian Foreign Minister Penny Wong, but the latter was unavailable to meet her on Monday.
ments is expanded dialysis support.
PhilHealth has increased the coverage of hemodialysis sessions from 90 to 156 per year enough to sustain the recommended three treatments per week. The reimbursement per session has also been raised from P2,600 to P6,350, bringing total annual support for dialysis patients to nearly‚ P1 million.
Peritoneal dialysis benefits have likewise been expanded to P00,000 annually for adults and P1.2 million for children. Pediatric kidney transplants are now covered up to P2.1 million, while adult transplants will receive more than P1 million in total coverage, including post-transplant care, lab tests, and essential medicines.
‘‘These are life-changing num-
tarian cooperation.
President Ferdinand Marcos Jr. ratified the deal on November 5, and the Philippine Senate approved it on December 16.
Japanese Defense Minister Gen Nakatani and Philippine Defense Secretary Gilberto Teodoro earlier agreed to bolster military ties between Japan’s Self-Defense Forces (SDF) and the Armed Forces of the Philippines, amid rising tensions and increased military activity by China in the East and South China seas.
The South China Sea issue, according to a Japanese official, is directly tied to the peace and stability of the Indo-Pacific and is a legitimate
she said on X, urging Iran to "engage seriously in a credible diplomatic process.”
Trump's ceasefire announcement came just hours after Iran launched strikes against an American military base in Qatar, which he described as "weak" retaliation for US strikes over the weekend against Iranian nuclear sites.
Qatar's prime minister on Tuesday said Iran's missile strikes targeting the US base on Qatari soil were an "unacceptable" attack on the country.
"The attack on the State of Qatar is an unacceptable act, especially that the State of Qatar has been making great diplomatic efforts in order to have the situation deescalated," Sheikh Mohammed bin Abdulrahman bin Jassim Al-Thani told reporters.
being finalized.
The first batch of overseas Filipino workers (OFWs) repatriated from the Middle East is currently aboard Qatar Airways Flight QR 934, expected to arrive home safely on Tuesday night.
As this developed, 31 Filipinos from the Middle East – 26 OFWs from Israel, three from Jordan, one from Palestine, and one from Qatar – arrived in the country yesterday evening.
Department of Migrant Workers Secretary Hans Leo Cacdac said the repatriates will be provided with immediate financial support amounting to P150,000, on top of airport assistance, including temporary shelter and transportation to
“So, I will not be visiting Australian government officials for this visit. But I do hope that I can meet them in my next visit in the future,” the Vice President said.
"No Filipino, especially a public servant with 34 years of dedicated service as mayor, vice mayor, and congressman of Davao City, and President of the Republic, should be detained or tried by a foreign tribunal for alleged crimes committed in the Philippines," Padilla’s resolution stated.
The measure was originally submitted Monday, but rejected due to congressional rules at the close of the 19th Congress.
Padilla argued that the move was essential for national reconciliation, asserting that the Philippines must take the lead in addressing any alleged offenses committed within its borders.
"The Senate, as representatives of the Filipino people, cannot ignore the widespread support for former President Duterte and his repatriation," the document read.
The senator’s resolution noted that the government should continue its own investigations into Duterte’s con-
bers,’’ Romualdez said. ‘‘But more importantly, these are lifelines for families who have been praying for relief.’’
The Speaker also praised PhilHealth’s rollout of facility-based outpatient emergency care a reform he championed to ensure that emergency room visits are covered even if the patient is not admitted. This addresses the common issue where patients are forced to leave emergency rooms without treatment due to unaffordable fees.
In addition, PhilHealth has expanded support for heart-related conditions, another advocacy area raised by the House. Benefits now include P130,000 for non-surgical treatment of heart attacks, up to P530,000 for procedures such as angioplasty, and
concern of the international community.
Kazuya reaffirmed Japan’s solidarity with the Philippines in promoting a shared vision of a free and open Indo-Pacific. ‘‘The Philippines is an important strategic partner of Japan for peace and stability in the region, as it is a maritime nation and a neighbor that shares sea lanes with Japan and faces similar strategic challenges at sea,’’ he said.
‘‘We recognize that the principles of freedom of navigation, adherence to international law, and respect for sovereignty are essential to the continued prosperity and security of our peoples,’’ he added. In support of this shared vision,
Iran's foreign minister, for his part, said the attack was not against its Gulf neighbor but an act of "self-defense" after US strikes on Iranian nuclear sites. "The missile operation by the Iranian Armed Forces targeting Al-Udeid base was carried out within the framework of Iran's legitimate right to selfdefense," Araghchi said in a phone call with his Qatari counterpart Sheikh Mohammed bin Abdulrahman bin Jassim Al-Thani.
The Iranian attack "should in no way be interpreted as an action against the friendly and brotherly government of Qatar," he said, quoted in a statement from his ministry.
Iran and Israel have exchanged wave after wave of air strikes since Israel unleashed a major military of-
their respective provinces. The Technical Education and Skills Development Authority (TESDA) will also offer skills training for upskilling to facilitate redeployment options for the OFWs, while the Department of Trade and Industry (DTI) will provide support for business and livelihood opportunities.
Israel Ambassador to the Philippines Ilan Fluss said the two main border crossings in Israel — via Egypt and Jordan — are all fully operational, with complete security mechanisms in place to ensure the safety of all foreign nationals, including Filipinos intending to exit the Jewish state.
troversial war on drugs and prosecute any offenses based on domestic evidence.
He stressed the need to assert Philippine sovereignty and uphold its exclusive right to investigate and prosecute its own citizens under the Constitution and legal framework.
"Should a full repatriation free from ICC jurisdiction prove impracticable, the Philippine government should, at minimum, and on ad cautelam basis and without accepting ICC’s jurisdiction, secure former President Duterte’s interim release to the Philippines under conditions acceptable to the ICC," Padilla argued.
He adverted to the Principle of Complementarity under the Rome Statute, which limits ICC intervention to cases where a country is unwilling or unable to prosecute on its own.
"It is the solemn duty of the Senate to uphold the sovereignty of the Republic, reaffirm the right of the Filipino nation to determine the accountability of its citizens through its own legal system, and promote unity and reconciliation to strengthen national progress" Padilla stressed.
coverage for cardiac rehabilitation and ambulance services.
Romualdez emphasized that these reforms are the result of months of close coordination among the House of Representatives, PhilHealth, and the Department of Health. He said this progress shows what can happen when the government listens and responds to the people’s real needs.
‘‘Our goal is simple: no Filipino should be denied health care because of poverty. And today, we move one step closer to that goal.’’
He concluded by thanking President Ferdinand Marcos Jr., the leadership of PhilHealth, and the health sector for working together to fulfill the promise of universal health care.
Japan has participated in eight maritime cooperative activities (MCAs) conducted within the Philippines Exclusive Economic Zone (EEZ). ‘‘A few days ago, in Japan, Coast Guard agencies from Japan, the Philippines, and the United States conducted a trilateral exercise,’’ Kazuya said. ‘‘Japan will continue to cooperate with the international community, including the Philippines and the United States, to uphold a free and open international order based on the rule of law.’’
He also emphasized the need for peaceful dispute resolution grounded in international law, alongside efforts to steadily strengthen maritime security in the region.
fensive on June 13.
Israel said it has agreed to Trump's declaration of a ceasefire with Iran, adding that it has achieved all its objectives in the 12-day war with its arch-foe.
The Israeli government said: "Last night, Prime Minister Benjamin Netanyahu convened the cabinet... to announce that Israel had achieved all the objectives of Operation 'Rising Lion' and much more."
It added that it had removed "an immediate dual existential threat: nuclear and ballistic.”
Iran's top security body said the Islamic republic's forces had "compelled" Israel to "unilaterally" cease fire, adding that they remained "on high alert" to respond to "any act of aggression." AFP
PBBM... From A1
No suspects were apprehended, as the packages were found adrift and turned over by citizens to authorities.
"This is the biggest haul in the last six months, and among the largest in our history," President Marcos said, noting that P62 billion worth of shabu has been intercepted under his three-year watch. The drugs are scheduled for destruction in Capas, Tarlac, with the Philippine Drug Enforcement Agency (PDEA) conducting random chemical testing beforehand. The President called on members of the media to attend the event to ensure transparency, referencing past allegations that seized drugs were recycled and sold back into the streets.
"Let the public see it. Watch the testing. Watch the incineration. We want to assure everyone that what we confiscated will never make it back to the market," he said.
He credited the interception to increased vigilance among ordinary citizens and a renewed focus on border monitoring.
"This came as a result of the instruction I gave our authorities—to prioritize identifying the entry points of large-scale drug shipments," he said.
Beyond enforcement, President Marcos emphasized the administration’s evolving drug policy, which includes strengthening prevention programs, investing in rehabilitation for drug dependents, and maintaining a strong law enforcement presence, especially in neighborhoods and near schools.
He directed police not only to dismantle syndicates but also to pursue small-time street-level dealers.
"Even if it’s just someone selling in a neighborhood, it makes people feel unsafe," President Marcos said.
The president said the country is starting to see progress from this new approach.
"The new concept of the war against drugs is working," he said.
"And I think we are beginning to see the good effects of that policy," the president added.
On the last Friday of June, the Coast Guards of Japan, the United States, and the Philippines held their first-ever joint exercises in Japan. The drill, held in Kagoshima Bay in southwestern Japan, simulated a scenario in which a U.S. cargo ship and a Philippine fishing boat collided in international waters south of Kyushu, causing a fire and prompting a rescue mission.
Patrol boats from all three countries participated in the mock firefighting and rescue operations. ‘‘The drill was meaningful as it promoted mutual understanding and trust among on-site staff,’’said Naofumi Tsumura of Japan's 10th Regional Coast Guard Headquarters in Kagoshima.
access to key Philippine military bases under the Enhanced Defense Cooperation Agreement (EDCA).
President Marcos has repeatedly stated that these moves are meant to bolster national defense capabilities amid China’s growing aggressiveness in the WPS.


By Charles Dantes
MALACAÑANG on Monday defended the San Juanico Bridge as a vital cultural and historical landmark after Vice President Sara Duterte questioned its value as a tourist attraction.
Presidential Communications Office
(PCO) Undersecretary Claire Castro highlighted the enduring significance of the 2.16-kilometer bridge, which
DepEd to address school gap issues
connects Samar and Leyte, describing it as a symbol of Filipino engineering and national pride. “The San Juanico Bridge is a symbol
THE Department of Education (DepEd) has vowed to resolve persistent issues in the public school system as classes opened nationwide for School Year 2025–2026. President Ferdinand Marcos Jr. and Education Secretary Juan Edgardo Angara visited schools in Bulacan and Quezon City to check on preparations, including facility upgrades and support services. Marcos emphasized the importance of basic utilities, saying, “We’re making sure that everyone will have power and water. Those are the basic services [we should have] for the good of our youth’s education.” Angara, meanwhile, toured Taguig City, Laguna, and Agusan del Norte, where he led the energization of a remote campus, Datu Saldong Elementary School. Angara also inaugurated a new Alternative Learning System–Community Learning Center (ALSCLC) in Buenavista, Agusan del Norte. DepEd likewise rolled out the CLASS+ program, giving learners and teachers access to vital health services. Despite these efforts, Angara admitted major challenges remain—among them, classroom shortages and limited personnel. DepEd aims to build 15,000 new classrooms by 2027, while also strengthening child protection, mental health support, and teacher hiring. Janos Barbero
robbery
TWO suspects involved in a robbery-holdup were arrested hours after the crime through joint operations by Makati and Taguig police on June 22. The case was cracked quickly after a tip led authorities to track the victim’s stolen iPhone using the Find My Phone app. Makati police chief Col. Reycon Garduque led the initial follow-up operation. The suspects, identified by their aliases “Bayog” and “Ian,” were located along the C5 service road in Barangay Pinagsama, Taguig. They tried to flee and drew firearms, but officers were able to recover stolen items left behind. Recovered were camera gear, legal documents, and personal items linked to the victim. Later that evening, McKinley Hill Village security intercepted the suspects, leading to their arrest with help from Taguig police. Authorities recovered additional stolen goods, including the iPhone 15, IDs, and two illegal firearms. Charges have been filed, and inquest proceedings are underway before the Makati City Prosecutor’s Office. Vince Lopez NGO workers accused of terrorism acts cleared BACOLOD CITY—The last of five development workers accused of terrorism financing has surrendered to the Criminal Investigation and Detection Group (CIDG) in Negros Occidental on June 24. Felipe Gelle, accompanied by local media, surfaced months after the others were arrested in January. Gelle and four others—Clarissa Ramos, Levy Bantayan, Dharyl Albanez, and Perla Avillar—were all affiliated with the Paghidaet sa Kauswagan Development Group (PDG), an NGO working with farmers and indigenous communities in southern Negros. The military accused them of violating the Terrorism Financing Prevention and Suppression Act. PDG’s advocacy work had drawn suspicion, especially after its executive director, lawyer Ben Ramos, was gunned down years ago under mysterious circumstances. The others were arrested by virtue of a warrant from RTC Branch 31, Iloilo City, on January 15. Edwin Ombion
of beauty and engineering capabilities of that time, back in 1973,” Castro said during a press briefing. “Perhaps most of us weren’t even born yet—but until now, it’s still standing, it’s still there. The San Juanico Bridge is just in need of rehabilitation,” she added.
Castro’s remarks came after Vice President Duterte questioned why the bridge continues to be promoted as a tourist destination, suggesting that not all infrastructure projects are meant for tourism.
“The Golden Gate Bridge in San Francisco is 2.7 kilometers, just slightly longer than San Juanico, but
it’s world-renowned. Even El Marco Bridge in Spain, the shortest bridge at just six meters, is considered a tourist spot,” Castro said. “What’s painful is that we Filipinos sometimes tear down our own while lifting up the attractions of other countries.”
The San Juanico Bridge, built during the Marcos Sr. administration, remains a longstanding landmark in Eastern Visayas. Recent government efforts have aimed to boost its appeal by rehabilitating the structure and installing lighting features to enhance its nighttime visibility.


By Maricel V. Cruz
THE House prosecution panel on Tuesday criticized Vice President Sara Duterte’s legal response to her impeachment case, saying it contradicts her earlier “bloodbath” rhetoric and instead focuses solely on dismissing the case through procedural arguments. This came after the House confirmed receiving Duterte’s official reply on Monday in response to the summons issued by the Senate impeachment court. According to lawyer Antonio Audie Bucoy, spokesperson for the House prosecution team, the reply was a strategic effort to avoid addressing the core allegations.
“If you cannot answer the factual allegations, you resort to procedure. They shifted the issue to technicalities. They are hoping that through technical means, Vice President Sara can avoid accountability and have the case dismissed,” Bucoy said.
On Monday, Duterte filed an Answer Ad Cautelam, a conditional response questioning the Senate’s jurisdiction over the impeachment case. In it, she called the complaint legally baseless, procedurally flawed, and politically motivated. Bucoy emphasized that Duterte’s response did not rebut the substance of the allegations. “She has no factual or legal grounds in her answer. It was all procedural. This is classic wagging the dog. When substance cannot be addressed, they turn to process,” he said. When asked about the defense’s claim that the case is politically motivated, Bucoy responded: “Those who cannot face the facts, those who cannot prove the substance of their defense, resort to procedure. What we want is a factual and legal basis. That is not in their answer.”
Bucoy said the Vice President’s filing does not formally recognize the court’s jurisdiction. “What Vice President Duterte filed is not a reply but an Answer Ad Cautelam. That means she has not yet accepted or acknowledged the jurisdiction of the impeachment court.” He added that Duterte’s legal team filed an entry of appearance but failed to explain why the response was conditional. “So it’s as if she submitted an answer, but without recognizing the court’s authority.”
Despite this, Bucoy said the House prosecution team would still submit its formal reply, due Saturday. “We are ready to respond earlier,” he said.
Residents splash passersby with water during the
Baptist, the festival features vibrant street revelry and playful water dousing. Norman Cruz
By Rio N. Araja
THE Land Transportation Office (LTO) on Tuesday warned motorists against tampering with or covering their vehicle license plates to evade the No-Contact Apprehension Policy (NCAP). The agency said show cause orders would be issued to about 50 motorists caught violating the policy.
LTO Chief Vigor Mendoza II said violators will face both administra-
tive and criminal charges, in line with President Ferdinand Marcos Jr.’s directive to crack down on irresponsible drivers to uphold road safety.
“We have already caught a significant number of violators in coordination with the MMDA, and we expect to catch even more if people continue disrespecting the law,” Mendoza said. “Thousands of driver’s licenses were suspended, and show cause orders were issued during Holy Week alone for reckless driving and other violations. We will not hesitate to act, no matter how many are involved in this illegal scheme to avoid NCAP.”

On June 2, MMDA Special Operations Group head Gabriel Go submitted evidence to the LTO against around 50 motorists who were caught covering their license plates. He said this was in response to complaints and social media posts by some individuals promoting ways to evade NCAP penalties. LTO Executive Director Greg Pua said the agency would act swiftly on the MMDA’s complaint and is intensifying its crackdown on similar violations. He cited Republic Act 11235 (Motorcycle Crime Prevention Act), which penalizes plate tampering. “This is critical because some motorists are openly bragging on social media about how they avoid NCAP,” Pua added.
By Vince Lopez
THE Philippine National Police (PNP) on Tuesday announced the arrest of two suspects linked to the killing of Mauricio “Morrie” Pulhin, chief of technical staff of the House committee on ways and means. PNP spokesperson Brigadier Gen. Jean Fajardo said closed-circuit television (CCTV) footage helped trace the movements of the suspects, showing them entering the home of a man known as “Balong” to change clothes after the shooting.
“The shooter’s clothes were recovered there,” Fajardo said. The two arrested suspects—identified only
by their aliases “Balong” and “Jayson”—were captured in Caloocan and Quezon City, respectively. One acted as a middleman, while the other served as a lookout.
According to police, both suspects admitted they were hired for ₱30,000 to carry out the shooting. “Balong said they still haven’t been paid,” Fajardo added. Four other suspects remain at large. Initial investigation revealed Pulhin may have been targeted after he planned to file charges against the alleged masterminds. The arrested suspects are now in the custody of the Quezon City Police District.


Youths take center stage in World Drug Day ‘25
THE youths will take the lead in the Dangerous Drugs Board’s (DDB) nationwide activities for World Drug Day 2025 in Batac City, Ilocos Norte on June 26.
“We believe you are the future leaders of our nation, and as such, we are here to support and guide you every step of the way. With our youth-centered drug prevention programs and activities, we are building a country free from drug abuse,” DDB chairman Oscar Valenzuela said. He said young Filipinos are at the forefront of this year’s observance of the International Day Against Drug Abuse and Illicit Trafficking as the DDB rolls out a series of youth-led activities nationwide.
This year’s campaign centers on prevention, education and community empowerment, rallying the nation under the global theme “The Evidence is Clear: Invest in Prevention. Break the Cycle.” Rio N. Araja
Samal mayor extols Bataan gov’s charity
MAYOR Alex Acuzar of Samal, Bataan thanked Bataan Gov. Joet Garcia for donating laptops, tables, and chairs to the town’s municipal library.
The donation supports the town’s initiative to transform the public library into an i-Learning Hub (i-Learn sa Aklatan), a local government project that promotes access to modern learning tools and technology for all Samaleños, Acuzar said. He added that the governor’s charitable gesture will play a key role in improving the quality of education and digital learning in the community.
The mayor also cited the strong partnership between the Bataan provincial government and Samal local government in advancing education and development for the next generation. Butch Gunio
Korean War veterans mark ‘day of heroism
SURVIVING Filipino veterans of the Korean War in the 1950s gather together today to commemorate the conflict that “divided a nation, claimed the lives millions, and altered the course of international history.” This gathering of extraordinary gentlemen, held at the Peace Room of the Parañaque City Public Library, was meant not only to remember that fateful day of June 25, 1950 as a day of sorrow. but also a “time to honor the courage of those who fought, and to recommit to the promise of peace,” referring to the members of the Philippine Expeditionary Force to Korea (PEFTOK).
In his opening remarks, John Rommel Garces, chief branch manager of the Heavenly Culture, World Peace, Restoration of Light (HWPL), a South Koreabased international peace organization founded by Chairman Lee Man-hee, himself a Korean War veteran, reflected on the transformation of a soldier into a peace advocate, He urged all nations to pursue reconciliation over conflict.
By Maricel V. Cruz
THE Department of Social Welfare and Development (DSWD) is set to open a new satellite office on Commonwealth Ave., Quezon City in a bid to ease the discomfort of people seeking state financial subsidy through the Assistance to Individuals in Crisis Situation (AICS) and the Ayuda sa Kapos ang Kita Program (AKAP).
Edwin Morata, director of DSWD’s Protective Services Bureau-Crisis Intervention Division, said the satellite office will be located at the Paragon Place along
Commonwealth Ave. “It will still be near the DSWD central office, but we will be moving to Paragon Place beside the Ever Commonwealth. It is a three-story building, but two floors are for us,” Morata said.
The new facility will be inaugurated on June 26 to accommodate scheduled and walk-in clients of AKAP and AICS previously served by the central office.
The move aims to provide a “more efficient and client-friendly environment,” ensuring faster processing and improved service delivery, Morata said.
He said the building has an elevator, an escalator and air-conditioning system. . Morata said this DSWD initiative was driven by the feedback of clients and DSWD Secretary Rex Gatchalian’s “relentless push for people-centered developments in all agency programs and services.”
The initiative also heeds the call of President Ferdinand R. Marcos Jr. to make government programs and services more responsive both to the daily and long-term needs of the vulnerable, marginalized and in-crisis, Morata added.

By Joel E. Zurbano
A PLANE passenger’s power bank caught fire and exploded at Roxas Airport on Tuesday morning, according to the Civil Aviation Authority of the Philippines (CAAP).
No one was reported injured in the minor explosion which occurred at the Initial Security Screening Checkpoint (ISSCP) of the airport. The CAAP reported that around 6:36 a.m., airport personnel discovered a 72,000 milliampere-hour (mAh) power bank in the baggage of a female passenger bound for Manila. This gadget exceeded the allowable capacity of 160 watt-hours for devices permitted on board an aircraft. Initially, the passenger claimed that the power bank had been allowed on her inbound flight from Manila. However, she eventually agreed to turn it over to a companion outside the terminal. While
arrangements were being finalized, the power bank suddenly sparked and ignited on the inspection table.
“An airport security guard promptly responded and used a fire extinguisher to suppress the flames. Despite this intervention, the power bank exploded shortly after. Fortunately, the incident did not result in any injuries or significant damage,” said CAAP chief information officer Eric Apolonio.
Apolonio emphasized the importance of strict compliance with aviation safety regulations, particularly concerning lithium-ion powered devices such as power banks.
Just recently, a smoke was observed coming from Baggage Carousel 3 at Ninoy Aquino International Airport - Terminal 1.
An airport employee identified the source of the smoke as a power bank that had likely fallen from a passenger’s luggage into the carousel system.
By Rex Espiritu
THE P10-b drugs seized by the authorities off the coast of Zambales had Chinese characters, the Philippine Navy said on Tuesday.
“The shipment amounting to 1.5 tons with a market value of roughly P10 billion had markings that appeared to be Chinese in character.” Philippine Navy spokesman for the West Philippine Sea (WPS) Rear Admiral Roy Vincent Trinidad said in a press briefing at Villamor Air Base in Pasay City. The prohibited substance, found on Friday aboard a fishing boat off the off Zambales, was considered the biggest illegal drug apprehension in the history of the Philippine Navy in support of the national government’s campaign against illegal drugs.
Trinidad said a Chinese Malaysian national manning the boat with the drugs was arrested.
“Historically, there have been instances of large hauls of illicit drugs apprehended in the maritime domain, confiscated in our seas that had markings that appear to be Chinese characters.” Trinidad noted.
He also said this indicates the possibility of “another effort of the Chinese Communist Party to destroy the future generation of Filipinos by flooding our country with illicit drugs.”
“Hence, the Philippine Navy and the AFP (Armed Forces of the Philippines) had to extend (assistance to the antidrugs campaign) based on the guidance of our good Secretary of National Defense in the conduct of comprehensive archipelagic defense operations.
“We now extend our coverage all the way up to our EEZ and this particular operation is a result of your AFP conducting comprehensive archipelagic defense operations. It’s not far-fetched (this is an attempt of the Chinese Communist Party,” he added.
By Vito Barcelo
THE Commission on Elections (Comelec) has received the petition of Manila 6th District congressman-elect Joey Uy seeking to overturn the poll body’s decision invalidating his victory in the recent elections for alleged misrepresentation. The Comelec 2nd Division annulled Uy’s proclamation and recognized instead reelectionist and second-place finisher Bienvenido Abante, as the legitimate winner.
Uy was disqualified after the Comelec determined that he did not meet the constitutional requirement for natural-born Filipino as mandated by the Constitution. In his motion for reconsideration, Uy maintained that he is a natural-born Filipino, asserting that this claim is “clearly supported by factual evidence and was made in good faith,” and that his “personal history consistently confirms his authentic Filipino identity.”
In its ruling on June 18, the Comelec upheld Abante’s claim that Uy submitted a false declaration regarding his citizenship, in effect constituting material misrepresentation in his certificate of candidacy (COC).
Abante argued that Uy was not a Filipino citizen at birth by virtue of the 1935 Charter.


WHILE calls for a legislated ₱200 increase in the minimum wage have grown louder in the country, fueled by the rising cost of living an persistent economic inequality, there appears little chance that employers would agree to such proposals. Labor groups champion the proposal as a long-overdue relief for workers, but economists and employers caution against its broader repercussions on businesses and the job market.
A ₱200 wage hike could provide relief from inflation and high cost of living.
A compelling reason for a legislated wage increase is the growing gap between workers’ earnings and the real cost of living, particularly in urban areas such as Metro Manila, where daily expenses continue to soar due to inflation, making it difficult for minimum wage earners to afford basic needs such as food, housing, and transportation.
An additional ₱200 per day could significantly improve the quality of life for millions of low-income workers and their families.
Another sound argument for increasing the minimum wage of Filipino workers is that this could serve as a stimulus for domestic consumption. When workers have more disposable income, they tend to spend more on goods and services.
This uptick in consumer spending can fuel local businesses, potentially resulting in a positive ripple effect across the economy.
A legislated wage hike can also address widening income inequality.
Many believe that the current wagesetting mechanisms in the form of regional wage boards are inadequate in addressing nationwide disparities.
Standardizing and raising the minimum wage through legislation may promote more equitable wealth distribution and reduce poverty levels.
But there are also compelling arguments against a legislated wage increase. Its advocates claim that this would impose an undue burden on micro, small, and medium Enterprises . Many small businesses, which form the backbone of the Philippine economy, may not have the financial capacity to absorb the additional labor costs. This could force some businesses to lay off workers, reduce their workforce hours, or even shut down, counteracting the very purpose of the wage hike.
A significant wage increase could also lead to a rise in unemployment and discourage companies from hiring more workers due to higher costs.
It could accelerate automation or lead firms to outsource labor to countries with cheaper workforces. In the long run, this could reduce employment opportunities for low-skilled Filipino workers.
Then there’s the risk of inflationary pressure. Some economists warn that wage increases could contribute to in-
flation, as businesses might pass on the added labor costs to consumers in the form of higher prices.
What is needed, from where we sit, is to strike a balance between the welfare of workers and economic sustainability. Policymakers may need to explore phased implementation strategies, targeted subsidies for MSMEs, or complementary programs such as skills training and tax relief to soften potential negative impacts.
Moreover, careful monitoring and region-specific calibrations could ensure that the wage hike truly benefits workers without disproportionately harming smaller enterprises.
An additional P200 per day could significantly improve the quality of life for millions of lowincome workers and their families
Ultimately, the challenge lies not just in increasing wages but in crafting a policy that uplifts the workforce while maintaining an environment conducive to business growth and job creation.
Labor groups are calling on the Senate to convene the bicameral committee to reconcile and ratify the final version of the legislated hike bill.
Partido Manggagawa believes the Senate should not neglect its obligation to workers struggling under stagnant wages, while the House has the constitutional duty to ensure the timely enactment of important bills.
For its part, the Federation of Free Workers said the bicameral conference committee must not be affected by claims of mass layoffs, and should approve a P100-P200 wage increase.
The Senate passed its P100 wage hike bill (Senate Bill 2354) in February 2024, while the House of Representatives passed a P200 wage hike bill (House Bill 11376) without objections, suggesting that both houses recognize the need for a wage hike.
But the Philippine Chamber of Commerce and Industry, Employers Confederation of the Philippines and the Makati Business Club all warned that a legislated wage hike could push up prices while benefiting only minimum wage workers.
President Marcos Jr. supports moves for a workers’ minimum wage hike that both houses of Congress and the business sector have already agreed to be necessary, but maintains this should be undertaken by Regional Tripartite Wages and Productivity Boards in each region.
So how will the government solve the impasse?
(Email: ernhil@yahoo.com)

A WEEK before the 19th Congress adjourned sine die, I voted yes to House Bill 11376, which grants a P200 daily wage increase for our country’s minimum wage earners. I did it because it’s the right thing to do. Plain and simple. For years, Filipino workers have been asking not for luxury, not for excess, but for enough—enough to put food on the table, to keep a roof over their heads, to send their children to school. But while prices have continued to rise—food, fuel, electricity, even school supplies— wages have barely moved. That’s not fair. That’s not right. This P200 wage hike isn’t just about adjusting numbers. It’s about restoring dignity. It’s about making sure that a full day’s work translates to a decent, livable life. If you work hard, you should not go to bed hungry. You should not have to choose between rice and medicine. You should not live one crisis away from total collapse. Critics have raised concerns about
the impact on businesses. I understand those concerns. But let’s also look at the bigger picture. When workers earn more, they spend more—on food, clothes, transport, basic goods and services. That money goes right back into our local economy, helping businesses grow and stay afloat. More purchasing power means more economic activity.
This P200 wage hike isn’t just about adjusting numbers. It’s about restoring dignity
And the data supports this. According to research from the UP School of Labor and Industrial Relations (SOLAIR), the impact of a wage hike on inflation is very small, even negligible. That’s because inflation isn’t mainly caused


This is an AI-generated cartoon with the prompt: Generate a political cartoon in horizontal format reminiscent of pen and ink with tints. The central character, a rotund lady in green shirt with grey slacks, has a round torso and spindly legs that turn out to be three pairs of spider legs grabbing onto different money bags. The lady has a scrunched up face; instead of eyes it has distressed lines piling onto of each other. The nose is pug-like. She has a screaming mouth with fat jowls hanging at the side. She has chin length hair parted at the side and the color of milk tea. She is screaming ‘where did the debt go?’ Her torso has a pair of human hands in balled up fists swaying frantically. Meanwhile she is in an arachnid body stand on top of an intricate and gooey spiderweb with the sign ‘impunity.’
T‘A
HIS late in the day, Filipinos still have no idea whether we could expect an impeachment trial as envisioned by the Constitution at all.
Vice President Sara Duterte now wants her case dismissed for supposedly being baseless. Her trial must not proceed, she said, because the circumstances that surrounded the filing of the complaint were unconstitutional.
The case, she said in her response to the Senate, is “nothing more than a scrap of paper.”
What ever happened to the bloodbath that the VP said she expected to unleash during her trial? She uttered this challenge only last month.
It now appears that the progress of the impeachment trial would hinge on technicalities when all the people truly wanted was to get to the substance of the issue: why won’t Ms. Duterte come clean about how she spent her confidential funds?
by wages—it’s driven by supply issues, power costs, hoarding, smuggling, and inefficiencies in our systems.
We cannot keep blaming workers for inflation. They cannot be the whipping boys forever, especially when they are the ones carrying the weight of rising costs.
Some say this will cause job losses. But even Nobel Prize-winning economists like David Card, Joshua Angrist, and Guido Imbens have proven otherwise. Their research found no negative impact on employment after a wage increase. In fact, the last legislated wage hike in the Philippines—a P25 increase in 1989—was followed by a decrease in unemployment the following year.
There’s also the argument that this will drive away foreign investors. But the reality is, foreign investors don’t come to the Philippines just for cheap labor. They look for good infrastructure, affordable energy, skilled workers, and efficient government services. For the past 35 years, we’ve kept wages low through regional wage boards—and yet we’re still struggling to attract foreign direct investments. So clearly, it’s not just about wages.
Some will point out that this wage
We saw how our elected senators comported themselves when it came to deciding on whether or not to convene as an impeachment court. Some of the senators flaunted their political leanings, abandoning all pretense to impartiality even as they
What happened to the bloodbath?
had been sworn as senator-judges. They had the temerity to remand the complaint to the House of Representatives; fortunately, the latter acted swiftly and released a resolution saying that the complaint complied with the Constitution.
hike only helps formal workers—about 16 million people. But what about the 40 million in the informal economy?
The truth is: wage hikes help them, too. It sets a new standard, a benchmark for what fair compensation should be—a “lighthouse” effect. And when more people have money to spend, demand increases. This demand fuels informal sector growth. So yes, even tricycle drivers, sari-sari store owners, street vendors—they benefit too.
And here’s the most painful truth: almost all regional minimum wages in the country—except for NCR—are below the poverty threshold. That means even if you work full-time, you are still considered poor. That’s not just an economic issue. That’s a moral one.
It’s been 36 years since we last legislated a wage hike. Since then, our wage system has been left to regional boards that issue tiny “barya-barya” increases that do little to keep up with inflation. For decades, our workers have been asked to wait, to endure, to adjust.
But how much longer can they wait? How many more years must they survive on wages that don’t even match 1989 levels when adjusted for inflation?
As the world reels from uncertainty from the recent events in the Middle East, we are also reeling from the political theater that is unfolding in our own backyard. Surveys have shown, time and again, that Filipinos are most concerned with their economic prospects – being able to afford the prices of goods, landing jobs, earning fair wages. That they must be privy to all the drama, when all they want is to know how taxpayers’ money was released and spent, supposedly for their benefit, is an unnecessary insult. The impeachment complaint is a piece of paper all right – many pieces of it, to be sure – but it is never scrap because it embodies the people’s resort to Constitutional means to hold their officials accountable for their actions. The VP should stop stoking people’s emotions, alternating between talking tough and portraying herself the victim of persecution. She must instead take the opportunity afforded by the law as a platform to prove her innocence, if she is indeed that.
Back then, what P89 could buy would cost more than P600 today. But minimum wages outside NCR are still far below that level.
This is why the P200 wage increase is not just an economic necessity. It’s a moral and social obligation. It’s about correcting decades of injustice. It’s about lifting more than five million Filipino families out of the poverty trap. That is also why I voted yes—because I believe that no one who works full time should be poor. I believe in an economy that puts people first. And I believe that fair wages make for a stronger, fairer, and more resilient nation. As Saint Pope John Paul II reminds us in his encyclical Laborem Exercens, “Work is a key, probably the essential key, to the whole social question.” When we respect the dignity of labor by ensuring just wages, we begin to answer that social question with justice, compassion, and hope. It’s time we stop treating labor as a cost to be minimized and start seeing it as the engine of our economy. It’s time to give our workers what they rightfully deserve. And that’s why I stand firmly behind the P200 wage hike.





COMPROMISE DEAL. This photograph shows the North-Atlantic Treaty Organization’s flag alongside some of the flags of its member states at the venue where a NATO summit was being held in The Hague, on Tuesday. Ukraine’s President Volodymyr Zelenskyy was scheduled to participate in person Wednesday and Thursday when NATO members are expected to agree to a major increase in defense spending under pressure from US President at the gathering. NATO’s 32 countries have thrashed out a compromise deal to dedicate 3.5 percent to core military needs by 2035, and 1.5 percent to broader security-related areas like
WASHINGTON, DC—A divided US Supreme Court paved the way on Monday (Tuesday Manila time) for the Trump administration to resume deportations of undocumented migrants to countries that are not their own.
The unsigned order from the conservative-dominated top court came in response to an emergency appeal by the Justice Department to lift a stay imposed by a lower court on so-called third country deportations.
The Supreme Court did not provide an explanation for the decision and the three liberal justices dissented.
The original case challenging the third country deportations will now be heard by an appeals court but the Supreme Court’s move allows the removals to proceed for now. District Judge Brian Murphy had ordered a halt to third country deportations in April, saying migrants were not being given a “meaningful opportunity” to contest their expulsions. Murphy said they should get at least 15 days to challenge their deportation and provide evidence of whether they may be at risk of torture or death if expelled.
The original case involves the deportation of eight men -- two from Myanmar, two from Cuba, a Vietnamese man, a Laotian, a Mexican and one from South Sudan -- who the US authorities said were convicted violent criminals. They were being flown to impoverished war-torn South Sudan when Murphy’s order came down and have been held since at a US military base in Djibouti. AFP
THE HAGUE, Netherlands—NATO leaders will seek to lock in US President Donald Trump’s commitment to their alliance with a summit pledge to boost defense spending, as they gather Tuesday in The Hague with global tensions soaring over Iran.
The overriding focus of the gathering—which kicks off with dinner hosted by the Dutch king— has been on keeping Trump happy after his return to power sparked fears he could blow a hole in the sevendecade-old alliance.
From meeting his spending demand to limiting the participation
ARANYAPRATHET, Thailand—
Dozens of tourists and workers, some carrying children, were left stranded on Tuesday at Thailand’s main land crossing with Cambodia, after the army stopped almost all border traffic in an escalating territorial dispute.
Thailand has closed crossing points in in all seven border provinces to everyone except students and those seeking medical treatment, after a long-running row erupted into military clashes last month in which a Cambodian soldier was killed.
There was confusion at the Ban Khlong Luek checkpoint in Sa Kaeo province—the main crossing for people travelling overland to Cambodia’s Siem Reap, where the Angkor Wat complex is located.
Around 50 Cambodian workers, mostly vendors who regularly cross into Thailand for trade, found themselves stuck at the checkpoint, unable to return home.
“I wanted to go back last night but had to sleep at my shop instead because police didn’t allow me to cross,” said Malin Po, 38, a clothing seller.
“I usually cross every day because I come to work in Thailand and go back home to Cambodia.”
She said no one had explained why the checkpoint was closed, leaving many frustrated.
Riot police were stationed near the crossing point—a grand archway sealed shut with yellow railings—as people trudged back towards the Thai side after being turned away. AFP
of Ukraine’s President Volodymyr Zelenskyy, everything is being done to try to avoid the chances of a damaging confrontation with the volatile leader.
But despite the careful planning the meeting still risks being overshadowed by the fallout from Trump’s decision to strike Iran’s
A person drinks from a canister near the US Capitol on the National Mall in Washington, DC, on Tuesday, Manila time, as a significant heat wave hits the region. The United States is experiencing its first significant heat wave of the year, which began on June 20 across the Great Plains and expanding into parts of the Midwest and Great Lakes over the weekend, according to the National Weather Service. AFP
nuclear facilities.
Central to the effort to keep Trump on board—given his threat not to protect lower-spending NATO allies —will be a pledge to satisfy his insistence that members cough up five percent of their GDP on defence.
To give him a headline victory, NATO’s 32 countries have thrashed out a compromise deal to dedicate 3.5 percent to core military needs by 2035, and 1.5 percent to broader securityrelated areas like cybersecurity and infrastructure.
“This is a quantum leap that is ambitious, historic and fundamental to securing our future,” said NATO
chief Mark Rutte, who warns the alliance must be ready to confront the threat of a Russian attack within five years.
“We must navigate this era of radical uncertainty with agility, speed,” British Prime Minister Keir Starmer said Monday in announcing the UK’s commitment to meet NATO’s spending target.
In a joint Financial Times op-ed on the summit’s eve, French President Emmanuel Macron and German Chancellor Friedrich Merz likewise argued that Europe must rearm “not because someone asks us to, but because we are clear-eyed and owe it

NEW YORK—The high-profile trial of Sean “Diddy” Combs is approaching its final stretch, with both teams poised to rest their cases as soon as Tuesday.
Closing arguments are tentatively expected to begin on Thursday, after which jurors will be tasked with deciding the fate of the music mogul who faces life in prison if convicted.
The prosecution’s 34th and last witness is currently on the stand, and defense lawyers indicated Monday they do not plan on calling their own witnesses to testify in Manhattan federal court.
It’s not abnormal for defense teams to opt not to present a case;
Indonesia rescuers try to reach Brazilian tourist JAKARTA—Indonesian rescuers tried Tuesday to reach a Brazilian tourist who fell down a ravine at a volcano popular with hikers after spotting her unmoving body, authorities said.
The woman identified by relatives and media reports as Juliana Marins, 26, went missing on Saturday at Mount Rinjani on Lombok island, which neighbors Bali. Authorities think Marins fell and believe they sighted her on Monday but rescuers were held back because of bad weather.
“Yesterday morning we detected the victim. We deployed a team to the location but we were hampered by the very steep terrain and the foggy weather,” Muhammad Hariyadi, head of Lombok’s Mataram Search and Rescue Office, told AFP on Tuesday.
“When we detected her using a drone, she was not moving.” Rescuers said they were using thermal drones, mountaineering gear and a helicopter in a bid to reach the Brazilian, who was backpacking around Southeast Asia.
“One group is monitoring the evacuation using a thermal drone. The second team is doing the manual evacuation process with a rope as the main tool,” said Hariyadi.
“This morning around 50 rescuers have been dispatched and we plan to send a helicopter team to scour the location.”
An Instagram account set up by family and friends to call for her urgent rescue has amassed more than one million followers.
“Hang in there Juliana! Help is on the way!” read a post on the account. The Brazilian embassy in Jakarta did not immediately respond to an AFP request for comment. AFP
the obligation to prove guilt lies on prosecutors, and unless jurors decide they have, the defendant is presumed innocent.
Over seven weeks of testimony prosecutors drew connections across a web of witnesses, phone records and travel bookings, a bid to show that Combs was the kingpin of an enterprise comprised of highranking employees that carried out crimes including bribery, arson and kidnapping to enforce his power and satisfy his every desire.
The prosecution said the artist and entrepreneur trafficked women and men for drug-fueled sexual marathons, sometimes days-long
NGOs urge closing of Gaza aid group
UNITED NATIONS, New York—More than a dozen human rights organizations called Monday on the Gaza Humanitarian Foundation, whose aid distribution has seen chaotic and deadly scenes, to cease its operations, warning of possible complicity in war crimes.
“This new model of privatized, militarized aid distribution constitutes a radical and dangerous shift away from established international humanitarian relief operations,” the 15 organizations said in an open letter. It called the US-backed group’s operations “dehumanizing, repeatedly deadly and (contributing) to the forced displacement of the very population it purports to help.”
The groups urged GHF and all the organizations and individuals who have been supporting its work, to “to cease their operations.” “Failure to do so may expose these organizations... to further
tional law,” the letter warned. The signatories include the International Federation for Human Rights (FIDH), the Palestinian Center for Human Rights, the American Center for Constitutional Rights, and the International Commission of Jurists. AFP
encounters dubbed “freak-offs” or “hotel nights.”
Some of the events were filmed, and jurors have watched a number of sexually explicit clips.
Government attorneys are closing their questioning by offering reams of text messages and other records for jurors to review, documentation of dozens of freak-offs that they say also shows arrangements for prostitution and trafficking.
The 55-year-old denies the charges.
The defense’s decision not to call witnesses could indicate they believe their questioning of government witnesses could have cast enough doubt on the case against Combs. AFP
to our citizens to do so.”
In the run-up to the meeting, Spain had sparked fears of undermining the alliance’s carefully choreographed unity by refusing to commit to the headline figure of five percent.
But Rutte stressed Spain had not been granted an “opt-out” from the pledge.
“The summit will be historic,” US NATO ambassador Matthew Whitaker said.
“This summit is really about NATO’s credibility and we are urging all of our allies to step up to the plate and pay their fair share for transatlantic security.” AFP
Millions in eastern US sweat out 1st extreme heat wave of year
NEW YORK—A potentially lifethreatening heat wave enveloped the eastern third of the United States on Monday impacting nearly 160 million people, with temperatures this week expected to reach 102 degrees Fahrenheit (39 degrees Celsius) in the New York metropolitan area.
The country’s first significant scorching heat of the year triggered health warnings as it arrived over the weekend. Dangerously high temperatures are forecast through Wednesday in Washington, Baltimore, Philadelphia, New York City and Boston.
“This extreme heat will not just be uncomfortable and oppressive for New Yorkers,” warned Mayor Eric Adams, adding that each year heat claims the lives of 500 people in this city of eight million.
“It’s going to be brutal and dangerous if you do not treat it with the understanding that we want you to,” he added.
As sweltering heat baked the city, authorities urged seniors, people with health problems and those without air conditioning to stay hydrated and seek help at designated cooling centers such as libraries and recreation facilities.
Heat records tumbled across parts of the US Northeast. In Central Park, known as the lungs of Manhattan, Monday’s temperature of 96F (36C) tied a record that has stood since 1888, according to the National Weather Service. AFP

IT’S the girls’ turn to shine as the Fortheo Cup National Junior Tennis Championships caps its two-week run in Biñan City, Laguna, with top junior talents and rising stars battling it out at the South City Homes Recreation Center starting tomorrow (Thursday).
Fierce competition is expected in the premier 18-and-under division, bannered by Sandra Bautista, Joy Ansay, Jan Cadee Dagoon, Dania Bulanadi, Czarina Ilano, Justine Casiller, Frances Ilagan and Elyce Yuipco, all raring to stake their claim in the singles play of the Group 2 tournament sponsored by Fortheo Power Station.
For the first time, all four girls’ categories drew full 32-player fields –a strong testament to the growing support for the country’s longestrunning grassroots talent search, spearheaded by the Palawan Pawnshop program under president/CEO Bobby Castro.
The Biñan leg, supported by Threema, Ckap Roofing, Tier One Architects, Scrambowl and Altiche Tennis School, wraps up an actionpacked twin-week stretch, following the boys’ competitions last week and the Fortheo Cup leg in Valenzuela City last month.
The overwhelming number of entries prompted organizers to separate the boys’ and girls’ tournaments – an updated format now adopted to better accommodate players across multiple age divisions.
Doubles titles will also be contested in the 10-and-U, 14-and-U, and 18-and-U categories for both boys and girls. For details, contact tournament director Bobby Mangunay at 0915-4046464.
In singles, Dagoon, Bulanadi, and Casiller are also seeing action in the 16-and-U bracket, joined by Ays Gonzaga, Isabel Ataiza, Jasmine Sardona, Vania Parawa and Andrea Pamandanan.
Gonzaga, looking to sustain a hot streak, headlines the 14-and-U category alongside Shaner Gabaldon, Ataiza, Parawan, Athena Liwag, Isabel Calingasan, Jasmine Solis and Amanda Barrido.

HONG KONG—With thousands watching from the shores of Victoria Harbour, the Philippine Dragon Boat Federation (PDBF) once again proved that Filipino grit and teamwork can go toe-totoe with the best of the world – but their history with dragon boat racing goes back much further than this year’s podium fi nish.
Long before dragon boat became a Filipino sport, it was Hong Kong that first introduced it to the Philippines. Back in the 1980s, the country’s Olympic rowers were invited to race in Hong Kong – a turning point that would ignite the sport back home. “We didn’t even have dragon boat athletes back then — just Olympic rowers,” said Atty. Jay Pee Villanueva, PDBF President. “But we fell in love with the sport. Hong Kong even donated our very first boats. That’s how far our friendship goes,” he added. Since then, the Philippines has re-
turned year after year, becoming a regular in the Hong Kong International Dragon Boat Races since 2006. For PDBF, each race – in many ways – is a homecoming.
Competing in the 2025 Sun Life Hong Kong International Dragon Boat Races, the Philippine team paddled to a hard-fought silver medal in the 500m Women’s International Championship, along with five other strong finishes – keeping their three-year streak of podium placements since the event returned after the pandemic.
The regatta, one of the most prestig-
ious in the sport, brought together more than 4,500 athletes from 12 countries. For the Filipino paddlers, it wasn’t just about chasing medals; it was about representing the country with heart, discipline, and unity.
“This wasn’t an easy win. We trained for months, pushed through injuries, and sacrificed time away from our families. But when we were out there, all we thought about was making the country proud,” Villanueva added.
Aside from the silver in the women’s championship, the team also landed third runner-up finishes in the Women’s Grand Championship, the Mixed International Championship, and the Open International Silver Cup. Their open and mixed crews were not far behind either, proving the team’s strength across the board.
The Hong Kong Tourism Board, alongside the Hong Kong China Dragon Boat Association, brought the Tsim Sha Tsui waterfront to life packed with races, culture, and color. From fastpaced races to a fancy dress competi-
DEFTAC is set to open a franchise in Iloilo city on Saturday in its bid to expand its reach to share the art of the Brazilian jiu-jitsu and promote self defense, discipline and grit among sports-loving Filipinos.
“I am very excited to open our first DEFTAC Iloilo gym under the DEFTAC franchise as we have created many national champions, including a 3rd-place finish in the World Championship,” said chief Alvin Aguilar, first Filipino black belter and Founder of DEFTAC.
“I expect this gym to produce many champions from Iloilo,” added Aguilar, one of five big figures in the sport who will grace the grand opening of a gym at third floor of LBS Bldg. on Jalandoni St., Iloilo City.
Expected to witness the grand opening, which will be covered by regional TV news, are bemedalled jiu-jitsu artists, including include prof. May Masuda, Aielle Aguilar, Zony Zaldarriaga, and David Zaldarriaga.
Prof. Masuda is the first Filipina world champion and Asian Beach Games gold medalist. She also holds the distinction of the being the first jiu-jitsu Filipina black belter.
Aielle Aguilar, on the other hand, is a three-time, youngest Filipina world champion. Zony Zaldarriaga is chapter head of DEFTAC Iloilo, while David Zaldarriaga is a bronze medalist of a world tournament.
The grand launching will be preceded by a seminar at 9 a.m. to be conducted by Chief Alvin, Prof. May and Aielle Aguilar. Brazilian jiu-jitsu is a self-defense system, martial arts and combat sport based on grappling, ground fighting, and submission holds – something that DEFTAC stakeholders want to impart to as many Filipinos as possible.



LOS ANGELES—NBA superstar LeBron James worked out for the first time since suffering a knee injury two months ago, saying he felt great after posting video clips of his Monday session on social media.
The 40-year-old Los Angeles Lakers forward shared video on Instagram of a workout in New York, looking strong in clips after suffering sprained left knee ligaments in an April playoff loss to Minnesota.
“Man it felt good to get back out there today for the first time since my MCL injury (Almost 8 weeks ago),” James posted. “Been at it with my rehab & training regiment to get back to form.” James and the Lakers were eliminated by Minnesota in five games in the first round, with James uncertain about his future status
after being hurt in a collision with the Timberwolves’ Donte DiVincenzo.
Two months later, James looked like a player determined to be ready for pre-season training camp in October, although James still did not comment on his plans for the 2025-26 season.
“Obviously not where I wanna be ultimately but off to a good start,” James posted. “Damn what a GREAT FEELING!!”
James has a Sunday deadline to opt into a $52.2 million player contract option for next season with the Lakers, what would be his 23rd NBA campaign.
James is a four-time NBA champion and fourtime NBA Most Valuable Player, having won titles with Miami in 2012 and 2013, Cleveland in 2016 and the Lakers in 2020.
The three-time Olympic champion is also the NBA’s all-time scoring leader. AFP
tion, the event drew cheering crowds of locals and international visitors alike. There was no shortage of energy all weekend, with top teams from across Asia racing for both medals and national pride. While powerhouse crews from China, Thailand, and Taiwan claimed top honors in the final Open Grand Championship, the Philippines earned praise for its discipline and determination – qualities that have become the trademark of PDBF’s international campaigns.
“We want to keep showing the world what Filipino paddlers can do. We hope this win inspires more Filipinos to pick up a paddle, join a crew, and see where the water takes them,” Villanueva remarked.
As the team returns home, they carry stories of resilience, camaraderie, and another proud chapter in the growing legacy of Philippine dragon boat racing. To cap off the trip, Hong Kong Disneyland hosted the athletes for a day at the park for a well-earned break.
BUKIDNON—With qualification points for the North vs South Elite Junior Finals up for grabs, the country’s most promising junior golfers brace for a fierce battle in the ICTSI Del Monte Junior PGT Championship, which comes off the wraps today (Wednesday, June 25) at the challenging mountaintop layout of Del Monte Golf Club here.
The tournament ushers in the fourleg Mindanao swing of the nationwide series, which also includes stops at Pueblo de Oro (July 1-3), South Pacific (July 9-11) and Apo Golf (July 14-16). It is a key part of the VisayasMindanao circuit and marks a pivotal moment in the chase for spots in the prestigious Elite Junior Finals slated Sept. 30 to Oct. 3 at The Country Club in Laguna.
With only the best three results counting toward the rankings, players are expected to go all out – not just for the win, but for crucial points to stay in the hunt for one of four coveted berths per division in the Vis-Min series, which will culminate in a face-off with the top performers from the Luzon swing in the national finals. Although a number of Bukidnonbased players will be competing on familiar turf, recent results have shown that geography offers no guarantees in this highly competitive circuit. The Visayas campaigners, in particular, have proven they can thrive even in unfamiliar territory, setting the stage for a highly unpredictable and tightly contested event.
Leading the boys’ 15-18 category is Mactan leg winner Alexis Nailga, who looks to sustain his form against a stacked field that includes last year’s match play champion and fellow Bukidnon bet and last year’s Match Play Finals winner Clement Ordeneza. But they’ll be challenged by Visayan standouts Nyito and Roman Tiongko of Cebu, and Bacolod’s Santi Asuncion – all eyeing a turnaround after near-misses in previous legs of the 54-hole tournament.
WEDNESDAY, JUNE 25, 2025

RIERA U. MALLARI, Editor
RANDY M. CALUAG, Asst. Editor
EDGARD HILARIO, Asst. Editor

By Randy M. Caluag
AS the Philippine para team gears up for bigger battles ahead, Kathleen Pedrosa gave the Philippines something to cheer about, clinching a bronze medal at the 2025 NSDF
Badminton Asia Para Badminton Championships held recently in Nakhon Ratchasima, Thailand. Pedrosa competed in the women’s singles SL4 class for athletes with lower li mb impairments.
She started strong, beating India’s Kanak Singh Jadaun, 21-5, 21-9, but lost her next match to Indonesia’s top seed Khalimatus Sadiyah Sukohandoko, 12-21, 11-21.
With a 1-1 record, Pedrosa advanced to the semifinals, where she faced India’s second seed Palak Kohli. Despite a valiant effort, she lost 5-21, 13-21. Still, Pedrosa proudly brought home the bronze medal, sharing the podium with Thailand’s Chanida Srinavakul. Kohli went on to settle for the silver, while Sukohandoko claimed the gold. Meanwhile, the Philippine para table tennis team has flown to Chinese Taipei for the ITTF World Para Future Taipei 2025, happening from June 26 to 29.
The team includes 15 athletes, led by ASEAN Para Games medalists Billy Cartera and Leo Macalanda. They are accompanied by coaches Louie Eballa, Gerald Tuazon, and Peter Francisco, under the guidance of PHILSPADA secretary-general Goody Custodio.
The tournament will serve as early preparation for the 2026 ASEAN Para Games.



Cignal reloads with 4 new players ahead of Spikers’ Turf
CIGNAL is determined to extend its championship streak as it retools early, signing four new players ahead of its 2025 Spikers’ Turf title defense.
The HD Spikers, the longesttenured professional squad in Philippine men’s volleyball, have welcomed opposite spiker Jayrack Dela Noche, outside hitter Vince Maglinao, middle blocker KC Andrade, and Fil-Canadian libero Lhexen Rabit into their roster.
“We’re looking to continue to build on the Cignal HD brand of excellence for men’s volleyball,” said HD Spikers head coach Dexter Clamor.
“Kami nga ‘yung pinakamatagal na pro squad here sa Philippines and we’re always looking for ways to improve. Hopefully, with these new additions, we’ll be ready to defend our crown in the upcoming conferences.”
Jayrack Dela Noche, a former UST Golden Spiker, brings his collegiate experience to the pros after graduating with a degree in Fitness and Sports Management from the España-based university.
A consistent force on the right pin, Dela Noche earned the Best Opposite Spiker award in UAAP Season 85 and led his team to back-to-back runner-up finishes in Seasons 85 and 86. He also gained international exposure as a member of the Philippine national team during the 2023 Southeast Asian Games in Cambodia.
Former DLSU Green Spiker Vince Maglinao is also making the leap to the pros after completing his UAAP eligibility.

BEST FOR
By Peter Atencio
AFTER leading Kaya FCIloilo to its second straight PFF Women’s League crown, team skipper Hali Long and two other teammates are now headed for Phnom Penh, Cambodia.
This time, Long, who was hailed as the league’s Most Valuable Players in tournament, will rejoin the Philippine women’s national football team in its coming campaign in the Asian Football Confederation (AFC) Women’s Asian Cup Australia 2026 Qualifiers.
“I will now focus on our campaign in Cambodia, can’t wait to catch up with my teammates,” said Long, who is rejoining the Filipinas, with Kaya teammates,
The Filipinas are competing with three key players absent, namely Katrina Guilliou and Reina Bonta, both unavailable, and Sarina Bolden, who is undergoing rehabilitation from an injury.
But coach Mark Torcaso assured that the Filipinas are still a very competitive group.
“Whoever we will play, we’ll be doing our best to put up a performance,” added Long, who boasts of 90 international appearance, including a friendly with Chinese Taipei.
Among the key figures back are Sara Eggesvik, Jaclyn Sawicki, Olivia, McDaniel, Angela Beard, Jessika Cowart, Chandler McDaniel, Malea Cesar, Isabella Pasion, Janae Defazio, and Kaya Hawkinson.
Also returning after a brief absence are Quinley Quezada, Sofia Wunsch, Meryll Serrano, and Carleigh Frilles.
Youth standouts, like Nina Mathelus, Gabrielle Baker, Alexa Pino, Ava Villapando, and Chayse Ying.


THE Philippine Admirals 12-under team will compete in one of the most prestigious little league baseball competitions in the world, the Babe Ruth World Series in Branson, Missouri from August 5 to 17.
This is the first time that the Philippines Admiral 12-under team will take part in this prestigious event after its qualification by winning the national tournament last May 2 to 11 in Clark, Pampanga.
The Philippines, aside from the 12-under squad, will also be represented in every age division, namely 10-under, 14-under, 16-under, and 18-under.
“We, the 12-under team won our ticket to the US by winning the local national tournament in Clark, Pampanga last May. We beat six other teams that played in that division,” team member Noah Matthew Escalona said. “We are the Admi-
Tagaytay City
A BRAND new indoor velodrome now cast a shadow over a similarly International Cycling Union (UCI)-grade BMX track, but perched in the heart of

Jonash Ponce, a former national team player and assistant coach Adrian Bernardo, a current national team member.
The players are Escalona, Ethan Lewis Yu, Lucas Paolo Amante, Luis Matteo Salvador, Aidan Lucas Sikat, Diego Sebastian Sebollena, Grant Zachary Bacarisas, Angelo Gabriel Mendoza, Pierre Francis Rizo, Yugiene Gorpido, Alvaro Ivan Azurin, Thian Pio Dizon, Lucio Isandro Reyes, and Nicholas Alfredo Abril.
Most of the members of the team are from Southridge School, while the others came from La Salle Greenhills, a public schools in both Pasig City and Muntinlupa City.
The team consists of 14 players and two coaches —head coach
Members of Philippine Admirals’ 12-under team are shown here. rals, we are baseball, and we will do our best out there for our country, the Philippines.” Teams from America, Japan, and Chinese Taipei, among others, are expected to join the competition.
“We train two to three times a week and travel all over to look for practice games and prepare well for the coming tournament,” Escalona added.
tribute to Dr. Jose P. Rizal, the fencer, with statue at City Hall
Dr. Jose P. Rizal clad in fencing gear greeting everyone at the main entrance of the new City Hall.



“It’s a tribute to our National Hero the sportsman, the athlete,” said Abraham “Bambol” Tolentino, the outgoing mayor who’s left a legacy not only as an excellent leader of the world-famous city but as the father of all Philippine sports.
“We Filipinos know very well that Dr. Jose Rizal excelled in everything he engaged in and in sports, he was a fencer par excellance, a sharp shooter and if there were titles during his time, a grandmaster of ahedres— chess,” added Tolentino, president of the Philippine Olympic Committee and PhilCycling. A string of celebratory events marked the introduction of Dr. Rizal the fencer at City Hall—inauguration of the 250-meter wooden Tagaytay City Velodrome that helped highlight blessing ceremonies for more than a dozen brand new facilities including the mod-
ern-designed City Hall along Isaac Tolentino Avenue.
Tolentino brought members of the POC Executive Committee—onboard the city’s e-trikes—after their meeting at Papa Bolo Brewery and Restaurant before heading to the velodrome where close to 2,000 athletes, sports officials and Tagaytay City crowd witnessed the inauguration of the first of its kind— and one of a few in the Asean region— cycling facility.
On hand to lead the ribbon-cutting ceremony with Tolentino and Cavite’s first woman governor, Athena Tolentino, was Asian Cycling Confederation president Dato’ Amarjit Singh Gill as well as Philippine Paralympic Committee president Mike Barredo, Tagaytay City Vice Mayor Agnes Tolentino and Cavite Eighth District Rep. Aniela Tolentino.
Double Olympic gymnastics gold
Carlos Yulo and

BDO Unibank Inc. president and chief executive Nestor Tan was elected president of the International Monetary Conference (IMC) for the 2025–2026 term. He is the first Filipino to hold the position. His election took place during the IMC’s annual gathering in Brussels, Belgium. The IMC is a non-profit organization made up of chairpersons and chief executives from 58 of the world’s largest financial institutions across 31 countries. Past presidents include Johan Thijis, CEO of KBC Group and Carlos Torres Vila, chair of BBVA. Since its founding in 1954, the IMC has played a key role



in shaping international banking practices and policies. It provides a private forum for dialogue among leading commercial banks, central bank governors, senior government officials, and top executives from global financial organizations such as the International Monetary Fund and the World Bank. Tan’s election “reflects his extensive expertise in banking and finance and affirms his leadership standing in the global banking community,” BDO said in a statement. It also recognizes BDO’s consistent performance and growing influence in the regional and global financial sectors.
or included VAT in their registered tax type/form should amend their registration information accordingly.
RMC No. 58-2025 provides that the extended deadline does not exempt NRDSPs from their tax obligations.
BIR defines NDRSP as a digital service provider (NDSP) that has no physical presence in the Philippines.
The extension, announced in BIR Revenue Memorandum Circular (RMC) No. 58-2025, comes in response to the unavailability of the VAT on digital services (VDS) portal and the online registration and update
system (ORUS) due to ongoing system migration activities.
This aims to provide NRDSPs with sufficient time to comply with registration requirements.
The circular clarifies that existing BIR-registered NRDSPs that have not updated their classification to “nonresident digital service provider”
Non-registration for VAT does not relieve them of the obligation to file required tax returns and pay corresponding taxes, the BIR said.
Business buyers or customers remain liable to file appropriate remittance returns and withhold and remit VAT due on digital service purchases within the period

By Darwin G. Amojelar
GRAB, Southeast Asia’s leading superapp, teamed up with the Department of Information and Communications Technology (DICT), the Department of Transportation (DOTr) and Megaworld Corp. to launch a pilot study on drone-powered commercial delivery in the Philippines. The initiative aims to explore how unmanned aerial vehicles can transform urban logistics in one of the region’s most densely populated areas, potentially speeding up deliveries of timesensitive items by avoiding traffic.

The pilot will explore a hybrid delivery model. Grab delivery-partners will handle pick-ups and drop-offs from dedicated drone landing stations, while drones will manage the in-between journey for faster, more seamless deliveries.
“We are constantly exploring new technologies that could help us serve our communities better, such as drone-powered deliveries,” said Ronald Roda, managing director of Grab Philippines.
“This pilot is an opportunity for us to learn and understand how drone deliveries might work in the Philippine con-
text, from dense urban neighborhoods to underserved areas,” said Roda.
“We’re optimistic about the insights this pilot will bring, and we look forward to co-creating solutions that benefit everyone in the ecosystem –from consumers, merchant-partners, and our delivery-partners,” he said.
The Philippines’ archipelagic layout and growing reliance on e-commerce make it an ideal testbed for drone-based logistics. The pilot also represents a broader push to modernize transport and delivery systems while ensuring that new technologies are deployed responsibly.
By Alena Mae S. Flores
THE Middle East crisis presents an opportunity for renewable energy and enhanced energy security, the Philippine Solar
prescribed by the National Internal Revenue Code of 1997, as amended and BIR regulations, it said.
BIR Commissioner Romeo Lumagui Jr. encouraged “all affected NRDSPs and businesses engaged in digital services to closely monitor further announcements of the BIR and to ensure timely compliance with the Bureau’s registration requirements once the VDS Portal and ORUS become available.”
12,800


70



12 Dollar millionaires in

PH millionaires grew by a third in past decade
THE population of high-networth individuals (HNWIs) in the Philippines, defined as those with assets of $1 million or more, increase 32 percent over the past decade to about 12,800 in 2025, according to the newly released Henley Private Wealth Migration Report 2025.
“The Philippines now has an estimated 12,800 HNWIs, including 70 centi-millionaires and 12 billionaires,” the report said. “Over the past decade, the country has recorded a remarkable 32-percent increase in its HNWI population, positioning it as an economic powerhouse in the region.”
“This consistent growth reflects the country’s emerging entrepreneurial class, its maturing financial markets, and its expanding real estate and services sectors. While it is not yet among the top destinations for incoming millionaires globally, the Philippines’ stability and growing wealth base stands out and creates a strong foundation for future investment migration,” said Scott Moore, managing director for Southeast Asia at Henley & Partners. Globally, a record 142,000 millionaires are expected to migrate in 2025, marking a new high in international wealth relocation. While the United Kingdom is projected to experience the largest net loss of millionaires in history, with 16,500 HNWIs anticipated to depart, Southeast Asia is witnessing a different trend. At the heart of this regional dynamic is the Philippines, showing steady domestic wealth growth and signaling long-term economic promise.
By Alena Mae S. Flores
THE Department of Energy (DOE) announced Tuesday its aims to complete the Smart and Green Grid Plan (SGGP) by September.
The initiative aims to seamlessly integrate additional renewable energy (RE) capacity into the Philippines’ power grid.
The SGGP will establish a robust policy and mechanism for timely transmission project implementation and efficient system operation. It seeks to enable the seamless integration of large-scale renewable energy, including up to 50 gigawatts of offshore wind and 4.8 GW of nuclear by 2050.
“The SGGP development started in September 2023 and is scheduled for completion by September of this year,”
DOE Undersecretary Rowena Guevara said during the Conference on German Technologies for Renewable Energy Integration in the Philippines. The conference was hosted by the GermanPhilippine Chamber of Commerce and Industry (GPCCI) in cooperation with the Renewable Energy Association of the Philippines (REAP) at Shangri-La Makati.
Guevara stated that the SGGP seeks to enhance grid reliability and resiliency through advanced transmission technologies and smart grid solutions.
“The plan also focuses on connecting remote RE sources to key demand centers by developing new transmission corridors and subsea cables,” she
added. SGGP Phase 2, Guevara noted, focuses on developing a transmission timeline to support large-scale RE integration, prioritizing offshore wind and other high-capacity sources.
“It aims to modernize the grid to meet 2050 peak demand, enable over 50 percent RE share by 2040, and enhance energy security and affordability,” she said.
The SGGP is an offshoot of the DOE’s Department Circular on “Providing a National Smart Grid Policy Framework for the Philippine Electric Power Industry and Roadmap for Distribution Utilities,” issued on Feb. 6, 2020.
“The policy envisioned the Philippine Power Industry having a smart grid with its necessary drivers. Deregulation, Decentralization and Democratization are in EPIRA, Decarbonization is in the RE Act, while Digitalization is the primary role of Smart Grid,” Guevara explained. She said an enhanced smart grid model for the Philippines is envisioned to incorporate real-time, AI-enabled balancing and dispatch at both the transmission and distribution levels.

during a test drive at the Subic Bay Freeport. The e bus was acquired through Golden Asia Automotive Builders, Inc. Joseph Muego
THE Subic Bay Metropolitan Authority (SBMA) is set to launch pure battery electric buses (PBEB) within the year, a key step as the Subic Bay Freeport Zone (SBFZ) moves toward its goal of carbon neutrality.
SBMA chairman and administrator Eduardo Jose Aliño stated that the PBEB project aligns with the agency’s “Race to Carbon Neutrality” program, which aims to make the Freeport the first carbon-neutral economic zone in the Philippines.
Aliño added that the PBEB project will include the construction of fast electric vehicle charging stations (EVCS) at the motorpool area of the SBMA Maintenance and Transportation Department (MTD).
Another charging station, donated by the Department of Energy (DOE), will be installed along Argonaut Highway.
“Ten units of these pure battery electric buses were delivered here in Subic Bay Freeport last May 13,” Aliño said.
“We have road tested one of the buses on May 27 with several members of the SBMA Board. It is quite comfortable and provides easy access for persons with disabilities.”
For the upcoming launch, the SBMA has allotted a budget of P10 million for the construction of new bus stops and the rehabilitation of existing ones, with completion expected by December 2025.
In addition to the EVCS, the project also includes the renovation of the Kalaklan Gate Terminal, which serves as Subic Bay Freeport’s entry point for people coming from Zambales.
A total of 58 new bus stops will be constructed: eight around the Central Business District, 16 at the Cubi Area, six at theme park areas, 18 at the Binictican Housing area, and 10 at the Kalayaan Housing area.
The PBEBs were acquired through Golden Asia Automotive Builders Inc. and manufactured by Xiamen King Long United Automotive Industry Co. Ltd., a company founded in 1988 with over 30 years of bus manufacturing experience.
With a target to reduce carbon emissions by 30 percent by 2030 and achieve net-zero emissions by 2040, the SBMA is pushing to become the first Carbon Neutral Port in the country through initiatives such as the P250-million Carbon Neutral Port project, which includes shore power connections for ships.

MERALCO PowerGen Corp.
(MGEN) has signed two power supply agreements (PSAs) with EvoEnergi Inc., a newly licensed retail electricity supplier (RES).
The agreements support the delivery of both conventional and renewable energy to contestable customers.
The PSAs were inked through MGEN’s thermal and renewable energy arms — MThermal and MGreen — reflecting a shared commitment to advancing energy reliability and sustainability through strategic partnerships within the competitive retail electricity market.
MGEN is the power generation arm of Manila Electric Co.
These agreements aim to provide EvoEnergi with a diverse mix of energy sources for their clients at a
competitive offer. Under the deals,
MGEN’s business units will supply enough energy to serve 62,000 households from both renewable and thermal sources.
“This partnership with EvoEnergi reflects the strength of MGEN’s diversified energy portfolio,” said Emmanuel Rubio, MGEN president and chief executive.
“By combining conventional and renewable sources, we are helping meet the evolving needs of the retail electricity market while supporting the country’s transition to a cleaner and more secure energy future.”
EvoEnergi, an affiliate of D&L Industries Inc. — a publicly listed company involved in product customization, development and specialization for the food, chemicals, plastics and consumer

TOP LINE BUSINESS DEVELOPMENT CORP.
Contact No. (032) 505 6058


products ODM industries
entered the energy market with a strong industrial heritage and a forward-looking approach to sustainability.
EvoEnergi is also among the first RES companies in the Philippines to successfully implement the Retail Aggregation Program (RAP), which enables multiple customers to consolidate their demand and access competitive electricity supply. This agreement expands the reach of MGEN’s renewable arm in providing renewable energy solutions beyond government programs like the Green Energy Option and Auction Programs. It also supports EvoEnergi in enhancing its supply portfolio while helping meet Renewable Portfolio Standards (RPS) obligations.
19F Latitude Corporate Center, Mindanao Avenue, Cebu Business Park, Cebu City, Philippines
NOTICE OF ANNUAL MEETING OF THE STOCKHOLDERS OF
TOP LINE BUSINESS DEVELOPMENT CORP.
Please take notice that the 2025 Annual Meeting of Stockholders of TOP LINE BUSINESS DEVELOPMENT CORP. (the “Corporation”) shall be held on July 18, 2025, Friday at 8:30 am via hybrid of remote communication through teleconferencing and/or videoconferencing, and in -person attendance at the Salon de España, Casino Español de Cebu, 107 -109 V. Ranudo Street, Cebu City, in accordance with the rules and regulations of the Securities and Exchange Commission, with the following program:
8:30 - 9:30 am Registration
9:30 -10:30 am Annual Stockholders’ Meeting Proper
The Agenda for the 2025 Annual Stockholders’ Meeting shall be as follows:
1. Call to Order
2. Proof of notice of the meeting and existence of quorum
3. Chairman and President’s Message
4. Reading and approval of the Minutes of the Annual Meeting of the Stockholders held on July 12, 2024
5. Management Presentation and Approval of the Audited Financial Statements for the year ended December 31, 2024
6. Amendment of By Laws – Amendment of date of Annual Stockholders’ Meeting from July 12 of every year to Second Friday of July
7. Appointment of External Auditor
8. General ratification of all acts and resolutions of the Board of Directors and its committees, officers and management since the last annual stockholders’ meeting up to the date of this meeting
9. Election of Board of Directors
10. Other Matters
11. Adjournment
The Board of Directors has fixed the Record Date at the end of trading hours of the Philippine Stock Exchange on June 16, 2025 for the determination of stockholders entitled to notice of and vote at such meeting and any adjournment thereof.
Registration starts at 8:30 a.m. and will close at exactly 9:15 a.m. Kindly bring a government issued identification card with photograph for registration purposes. The Corporation will allow attendance by remote communication and voting in absentia, subject to validation procedures.
Stockholders who will participate in the ASM by remote communication should pre-register at https://tinyurl.com/TOPASM2025 on or before July 7, 2025. Successful registrants will receive an email invitation with a complete guide on how to join the ASM and how to cast votes in absentia. For any registration concerns, please contact andreavargas@topline.ph. Please refer to the Definitive Information Statement on the guidelines for voting at the Corporation’s website at topline.ph Only stockholders who have successfully registered within the prescribed period, together with the stockholders who voted in absentia and by proxy, will be included in the determination of quorum.
Proxies, in the form provided by the Corporation, must be submitted to the Corporation’s Corporate Secretary, at the Principal Office of the Co rporation, or through andreavargas@topline.ph not later than July 7, 2025. The proxies shall be validated on July 11, 2025 at the Principal Office of the Company. The Corporate Secretary’s decision shall be final and binding on the shareholders WE ARE NOT, HOWEVER, SOLICITING PROXIES.
Stockholders may send their questions about the ASM and the Corporation to its Investor Relations Officer at andreavargas@topline.ph Pursuant to SEC Notice dated March 12, 2025, the Stockholders may examine the Definitive Information Statement, and Management Report on the Corporation’s website and through the PSE Edge Portal. There shall be an audio and video recording of the ASM. All votes cas t shall be validated by the Stock and Transfer Agent, Stock Transfer Service, Inc.
June 5,2025, Cebu City
For the Board of Directors,

BRIGITTE CARMEL L. MUELLER Corporate Secretary



By Othel V. Campos
SEVEN German companies specializing in power and energy are exploring potential partnerships in the Philippine renewable energy sector this week at a three-day conference in Makati City.
The “Conference on German Technologies for Renewable Energy Integration in the Philippines,” running from June 24 to 26 at Shangri-La Makati, is organized by the GermanPhilippine Chamber of Commerce and Industry (GPCCI) in collabora-
ACEN buys 25% stake in offshore wind developer
By Alena Mae S. Flores
ACEN Corp. said Tuesday it signed a deed of absolute sale with CI NMF Philippines C.V. to acquire a 25-percent stake in CI GMF II Camarines Offshore Wind Energy Corp. CI GMF II Camarines Offshore Wind is the holding company for CI NMF (PH) Corp., which will develop, construct, operate and maintain a planned 1-gigawatt (GW) offshore wind energy project in the provinces of Camarines Sur and Camarines Norte.
“The transaction supports ACEN’s growth by marking its entry into the country’s first large-scale offshore wind project,” ACEN said in a disclosure to the Philippine Stock Exchange.
“With a potential capacity of up to 1 GW, the project will expand the company’s renewable energy portfolio and help strengthen its role in the country’s clean energy transition,” it said.
ACEN, the listed energy company of the Ayala group, is acquiring 29,500 common shares of CI GMF II Camarines Offshore Wind at P100 per share. The company said the transaction “underscores the company’s commitment to unlocking the country’s vast offshore wind resources and accelerating the energy transition through the expansion of clean energy sources.”
“Offshore wind is poised to play a vital role in diversifying the country’s energy mix,” ACEN President and chief executive Eric Francia said earlier.
tion with Renewables Academy AG and the Renewable Energy Association of the Philippines (REAP). The event is part of the “Energy Solutions – Made in Germany” program, supported by Germany’s Federal Ministry for Economic Affairs
and Energy (BMWi).
“As the Philippines diversifies its energy mix, German companies have a strong opportunity to contribute with advanced technologies, engineering expertise, and collaborative ventures,” said GPCCI vice president Tristan Arwen Loveres.
“We are proud to provide a platform where German innovation aligns with Philippine energy priorities. This mission facilitated 68 business-tobusiness meetings to explore concrete partnerships,” Loveres said.
Participating German companies include battery manufacturer BAE

Batterien, solar PV developer Blueberry Energy, engineering consultancy Fichtner GmbH, electrolysis system provider H2 Core Systems, offshore wind specialist Reprocon GmbH, airborne wind innovator SkySails Power and hybrid PV power-togas firm SMA Altenso GmbH.
Department of Energy Undersecretary Rowena Guevara cited the critical role of smart grids and energy storage in the country’s energy transition.
“Our drive for energy transition not only builds sustainable infrastructure but also creates economic opportuni-
ties through a highly skilled workforce. The Department of Energy welcomes committed climate financing as a pathway to a clean and secure energy future,” said Guevara. The conference brought together around 70 key stakeholders from industry, government and the public sector to foster cooperation in renewable energy, smart grids, and energy storage technologies.
“There is immense potential for German technologies to support the Philippines’ energy goals,” said GPCCI president Marie Antoniette Mariano.
THE Philippines remains an ideal travel destination despite attracting one of the fewest visitors in Southeast Asia.
The Federation of Filipino Chinese Chambers of Commerce and Industry Inc. (FFCCCII), however, called for reforms such as making peace and order a national priority, adopting competitive visa policies, improving infrastructure and connectivity and implementing narrative rebranding.
FFCCCII president Victor Lim said he supports Department of Interior and Local Government (DILG) Secretary Juanito Victor Remulla’s remarks at the Hotel Sales and Mar-
keting Association’s (HSMA) Summit about the need to confront the systemic issues undermining the nation’s potential as a premier global destination.
Lim said while the Philippines possesses unparalleled competitive advantages in the ASEAN region, it languishes at sixth place in ASEAN tourist arrivals.
“While Thailand welcomed 36 million visitors in 2024 and Malaysia 25 million, the Philippines attracted a mere 5.95 million foreign tourists. This is not a failure of appeal but of assurance—travelers do not doubt our beauty; they doubt their safety. The perception of instability, fueled
DA blocks 25 tons of red onion from China The Department of Agriculture’s Bureau of Plant Industry
THE Philippine Economic Zone Authority (PEZA) said it endorsed a new information technology initiative by Tsuneishi Technical Services (Phils.) Inc. (TTSP) after a supplemental agreement was signed on June 18, 2025. PEZA director-general Tereso Panga and TTSP president Segismundo Exaltacion Jr. signed the agreement. Under the newly approved project, TTSP will undertake computer-aided retrofitting design using CADMATIC data output from 3D laser scanning at its facility in West Cebu Industrial Park, Balamban, Cebu. The project, valued at more than P50 million, is expected to begin commercial operations in June 2025. TTSP was founded in 1992 as an
by crime, political turbulence, and a perceived culture of impunity, has cast a shadow over our global image.
If we are to compete, we must act decisively,” said Lim.
Blessed with over 7,600 sun-kissed islands, some 1.65 million tourists visited the Philippines in the first quarter of 2025, based on data from the Department of Tourism (DoT).
This was far from its target of 8.4 million for 2025.
In 2024, the DoT failed to meet its 7.7 million target, ending the year with only 5.9 million tourists despite including returning overseas Filipinos and OFWs in the count. This figure lags behind Thailand’s
offshore ship design center for Japan’s Tsuneishi Shipbuilding Co. Ltd. in Hiroshima.
It has embraced innovation, partnering with the Asian Institute of Management to develop AI-assisted tools for ship design and representing the Philippines at the CADMATIC Digital Wave Forum in Spain. TTSP is a subsidiary of Tsuneishi Holdings (Cebu) Inc., which also owns Tsuneishi Heavy Industries (Cebu), Inc. (THI), operator of the Balamban shipyard established in partnership with Japan’s Tsuneishi Shipbuilding in 1994. TTSP has invested more than P100 million in its operations and currently employs more than 500 workers.
Othel V.
Campos
36 million visitors in 2024, Malaysia (25 million), Vietnam (17.6 million), Singapore (16.6 million), Indonesia (13.9 million) and Cambodia (6.7 million).
Local airfares are also too high, prompting more Filipino tourists to opt to travel abroad than visit Boracay, Siargao, Batanes, Bohol or Siquijor.
As of November 2024, a one-way trip to Batanes costs almost P8,000, while the cheapest roundtrip to Seoul is roughly P7,400. Tourism stakeholders are pleased that San Miguel Corp. has taken over the operation of Ninoy Aquino International Airport (NAIA).

drills and disaster response simulations. The two officials also discussed the possibility of establishing a PNP training center in the area through a usufruct arrangement. Othel V. Campos
THE National Commission of Senior Citizens (NCSC) will hold the 6th National Advisory Board (NAB) Conference and Midterm Assessment of the Philippine Plan of Action for Senior Citizens (PPASC) 2023—2028, today, 25 June 2025, from 8:00 AM to 5:00 PM, at The Great Eastern Hotel, Quezon City.
The NAB Conference brings together government agencies, local leaders, civil society groups, the private sector, and senior citizens’ organizations to track progress, align goals, and strengthen programs that support the elderly.
At the heart of the event is the Philippine Plan of Action for Senior Citizens, the national blueprint for improving senior care and support. This plan guides efforts to promote active aging, improve access to healthcare and social services, expand protections, and create inclusive, age-friendly communities.
This conference will assess how well the plan has worked so far and what can be improved. It aims to directly benefit older Filipinos by pushing for the following:
• Better care in communities through localized Senior Citizen Community Care Centers (SC3Cs) that offer essential services close to home;
• More benefits through updates on Republic Act No. 11982 or the Expanded Centenarian Act, which now gives recognition and cash gifts to seniors aged 80, 90, and 100 and above;
• Stronger support systems by adjusting programs based on real-life challenges faced by seniors—such as access to healthcare, income security, and elder abuse.
By holding this midterm review, the NCSC reinforces its commitment to leaving no elderly Filipino behind and to ensure that the PPASC remains a responsive policy that improves lives of the senior citizens in all communities.
By Harvey Sapigao
FILIPINO fermented foods have long been known to contain bacteria that offer health benefits, also known as probiotics. Burong isda, a traditional fermented fish from Pampanga, contains a bacterium called Limosilactobacillus fermentum (L. fermentum), which is closely related to the well-known Lactobacillus probiotics.
Researchers from UP Diliman College of Science (UPD-CS) combined genomic and laboratory analyses to provide a comprehensive probiotic profile of two L. fermentum strains in burong isda. Their multidimensional approach also revealed the strains’ antifungal benefits against Aspergillus fumigatus (A. fumigatus), one of the most common fungi affecting immunodeficient individuals. Their study not only lays the groundwork for developing new probiotic products but is also possibly the first to report the antifungal effects of L. fermentum against A. fumigatus.
“Historically, probiotic research in the Philippines has relied heavily on culturebased methods and basic molecular techniques,” said corresponding author Joshua Veluz from UPD-CS National Sciences Research Institute (NSRI). “This work underscores the value of combining genomics, metabolomics, and assays as a powerful and timely approach to uncovering the full probiotic potential of microbes found in Philippine fermented foods.” Veluz, a Kapampangan, said that he has a keen interest in this research because he grew up eating burong isda. He became curious about its potential after learning that Filipino fermented foods also have health benefits aside from their cultural significance. This curiosity led him to begin working on the study in 2019. “This personal and academic connection made the study deeply meaningful to me,” he said.
Along with Veluz, the study authors are Paul Christian Gloria and Dr. Maria Auxilia Siringan of UPD-CS NSRI, along with Dr. Irineo Dogma Jr. of the University of Santo Tomas (UST).

IN A world grappling with myriad challenges, the pursuit of social change often feels like an uphill battle. Yet, some individuals dedicate themselves to transforming this distant dream into a tangible reality. Among them is Zephaniah “Khalid” Mesa, the dynamic young founder behind Project Eight Initiatives, a burgeoning movement committed to empowering organizations and fostering advocacy in crucial areas such as mental health, agriculture, youth leadership, and entrepreneurship.
Project Eight Initiatives is not just an organization; it’s a testament to the power of collective action and strategic support. Khalid Mesa, the visionary behind this endeavor, recently shared insights into the heart and purpose driving this inspiring initiative.
“It started with a simple observation — a lot of organizations have the passion but lack the support system or structure to really grow their advocacy,” Mesa explained, detailing the genesis of Project Eight. His early involvement in youth organizations exposed him to the struggles many faced in sustaining momentum. This realization birthed the concept of Project Eight Initiatives, a platform designed to provide essential tools, mentorship, and networks to groups – particularly those focused on mental health, agriculture, youth development, and entrepreneurship.
Mesa’s strategic choice of focus areas stems from a deep understanding of community needs. “These are areas that directly affect the future of our communities,” he emphasized. He pointed out the often-overlooked importance of mental health, especially at the grassroots level, as foundational to sustainable development. Agriculture, he noted, is the economic backbone, yet it’s aging, necessitating greater youth involvement. Youth leadership, he believes, is crucial for preparing the next generation, while entrepreneurship empowers individuals to forge their own opportunities. “All of these work hand-in-hand in building resilient, self-
sufficient communities,” Mesa asserted. Project Eight Initiatives acts as a vital conduit, bridging small or emerging organizations with much-needed resources. “We serve as a bridge — connecting small or emerging organizations with resources, mentors, and capacity-building programs,” Mesa stated. The initiative offers a comprehensive suite of services, including workshops, strategic planning sessions, and assistance with communications and digital campaigns. Beyond practical support, Project Eight fosters a collaborative environment, creating “safe spaces where advocates from different sectors can collaborate, exchange ideas, and support each other. It’s not just about giving help; it’s about empowering others to create lasting change.”
Building a grassroots movement is not without its hurdles. Mesa acknowledged the challenges inherent in such an undertaking, including “funding, logistics, and sometimes even skepticism.” However, he attributes their resilience to a steadfast adherence to their core purpose. “We overcome them by staying grounded in our purpose. We partner with like-minded organizations and individuals who believe in what we do,” he explained. The most powerful motivator, he revealed, is the tangible impact of their work.
“What’s kept us going is the impact — when someone tells us they were able to launch their project, help their community, or find healing through our mental health programs, it reminds us that we’re doing something that matters.”

By Neil Gregori Garen
EVER feel like your goto weekend getaways just aren’t enough anymore?
Searching for a place that can clear your mind and lift your spirit at the same time?
A short flight away, Sa Pa, Vietnam could be the change of pace you didn’t know you were looking for. With its misty peaks, deep cultural heritage, and breathtaking views, this mountain town is perfect for young professionals craving something beyond the ordinary.
A highlands escape that feels like another world In a time of rushed weekends and sameold destinations, Sa Pa offers something rare: peacefulness that still feels vibrant. Nestled in the mountains of northern Vietnam, it’s a retreat that balances adventure, cultural depth, and mental clarity. We traveled this June, and it felt like stepping into a dream. The cool mountain air, the mist drifting through terraced hills, and the wide-open views made us pause and breathe it all in. Found in Lào Cai Province, Sa Pa is a beautiful mix of natural wonders and rich traditions. It’s the perfect pick for young professionals who want more than the usual beach trip or bustling city—and who still have the energy for treks and trails. Even getting there was an experience. From Hanoi, we rode a sleeper bus where you can lie down and even enjoy a light electric massage. No shoes allowed inside, but they’ll give you plastic covers. At the two stops along the way, free slippers are available so you don’t have to lace up again. The five-hour ride was smooth, and when we arrived, a shuttle was ready to bring us straight to the hotel. From there, getting around was simple—walkable streets, kind locals, and a slower rhythm that lets you take it all in.
As you explore, one thing might catch your attention. The town’s name, “Sa Pa,” is correctly written with a space, though you’ll also see “Sapa” spelled as one word in many signs. Both versions are widely accepted and used interchangeably. Culture below, heaven above The town itself has a calm charm. A French colonial-era church stands at the center, surrounded by mountain views. Around it, you’ll find restaurants and shops offering everything from local noodle dishes to Western-style comfort food. Many of the meals are vegan-friendly or strike a healthy balance between meat and vegetables—think nourishing soups, stir-fried greens, and fragrant local herbs. While we were there, we even met fellow Filipinos on vacation.
Some tried saying cảm ơn (thank you), while others taught locals to say salamat. To our surprise, many vendors already knew the word salamat—a lovely reminder of growing cultural connections. Not far from the town is Cat Cat Village, home to the
WEDNESDAY, JUNE 25, 2025
lifeandshow.manilastandard@gmail.com
NICKIE WANG, Editor
ANGELICA VILLANUEVA, Writer

JASPER VALDEZ, Writer



By Angelica Villanueva
ACTOR Jericho Rosales called on
the public to take part in cleaning up the country’s beaches after seeing piles of litter along the shore during a recent visit to this coastal city.
Jericho, who was in Tandag, Surigao del Sur, for a performance, took time to visit a nearby beach and shared photos and videos of plastic waste he found scattered along the coastline. Among the trash were plastic cups, wrappers, slippers, and used personal hygiene products. He posted the images on his Instagram Stories, using sarcastic captions to highlight the impact of improper waste disposal. On a photo of a discarded deodorant bottle, he wrote, “Mabango nga kilikili mo, ang baho naman ng trato mo sa kalikasan.” Another read, “Ang puti nga ng kilikili mo, ang itim naman ng budhi mo sa kalikasan.” In a separate video, he urged Filipinos to take responsibility for protecting the environment, saying clean surroundings can improve mental well-being and contribute to the local economy through tourism.
“Let’s help each other clean our oceans. A clean sea leads to better
tourism, and that means jobs,” he said.





FOR years, we have seen Gladys Reyes as the commanding presence in dramas, playing everything from strong maternal figures to unforgettable villains. But now, the multiawarded actress is exploring a new territory.

THE Society of Philippine Entertainment Editors (SPEEd) will honor media personalities and a film industry veteran at its 8th Entertainment Editors’ Choice (The Eddys) on July 20 at the Marriott Grand Ballroom in Newport World Resorts in Pasay City.
This year’s Joe Quirino Award will be given to showbiz columnist, TV host, and content creator Ogie Diaz, while veteran entertainment editor Crispina Belen will receive the Manny Pichel Award. The Joe Quirino Award is named after the late entertainment columnist and TV host who rose to fame in the 1970s and 1980s, while the Manny Pichel Award honors the legacy of a respected broadsheet entertainment editor.
Meanwhile, actor-entrepreneurproducer RS Francisco will be awarded the Isah V. Red Award, which recognizes individuals who have consistently supported and inspired underprivileged Filipinos.
Six seasoned actors—Laurice Guillen, Odette Khan, Perla Bautista, Pen Medina, and spouses Rosemarie Gil and Eddie Mesa—will be honored as Movie Icons.
The ceremony will also present 14 acting and technical awards for 2024

Gladys is going to sing (and dance) in the full-length musical, The Heart . And if there’s anything more exciting than seeing a seasoned actor try something new, it’s watching her throw herself into this new challenge with great excitement.
Gladys has signed on with Utmost Creatives Motion Pictures for this film, written and directed by Gat Alaman It features an ensemble that includes Angel Guardian, Kristoffer Martin, Elijah Alejo, Sean Lucas, Rey PJ Abellana, and real-life couples Robert Seña and Isay Alvarez, as well as Joshua Zamora and Jopay Paguia
“For the longest time, I dreamed of doing a musical—not just starring in one, but making one, even on stage,” Gladys shared with Manila Standard Entertainment during a recent media conference. “You know I love to sing, right? I’m not a professional singer, but I enjoy it—even just videoke.”
In the musical film, Gladys will play a character named Madonna—“not that Madonna,” she quipped— describing her role as a nanny with a bit of a Julie in Sound of Music vibe.
With an ensemble that includes musical theater legends, Gladys is not taking any shortcuts.
“Acting alone isn’t enough,” she said. “I want to come prepared vocally. It would be embarrassing otherwise, especially with Robert and Isay in the cast.”
To prepare, she enrolled in voice lessons at the




University of the Philippines. “On my first day, I was asked if I had any background in music. I said, ‘I don’t really.’ But I showed my teacher the piece I’d be using,” she recalled. “While the teacher plays the piano, I sing. Then they look at my weaknesses and strengths. I’m a bit throaty, so my voice gets tired easily.”
Determined to do justice to the role, Gladys even started learning the piano. “I didn’t want to have a hand double during the shoot,” she said. “If I can do it, I will. My family was really supportive. My son Kristoff said, ‘What, in one day? How did you do that?’ It’s hard, but if you really want to learn, there’s a way.”
The film reunites her with the team behind Unspoken Letters, and she spoke fondly of the collaboration. “It feels like a reunion movie for us. Direk and the rest of the production staff, they’re such a joy to work with.”








By Jenny Fatima Macatiag
AS FORMER Ilocos Sur Governor Luis “Chavit” Singson celebrates his birthday, it’s a fitting time to reflect on the man behind the public image. More than a political figure, Singson is known for his generosity, charisma, and dedication to making others happy.
His quiet but impactful philanthropy includes providing thousands of scholarships, helping shape future professionals and leaders. This reflects his strong belief in education and uplifting the next generation.
Singson’s charm and approachability continue to draw people to him, whether they’re old friends or strangers. Wherever he goes, he connects with people easily—proof of the lasting influence he holds across all walks of life.
Despite his age, Chavit remains energetic and disciplined. His day starts at 6:00 a.m. with exercise, Bible reading, and prayer—a morning ritual rooted in gratitude and reflection before a busy schedule. He often holds meetings at home, preferring a personal, grounded setting. Whether in Manila or Ilocos, his home is a center of hospitality. He gives equal attention to all guests, mixing serious talk with humor, creating a warm, lively atmosphere.



During a recent visit to Ilocos, he hosted dignitaries, including the Austrian ambassador, guiding them through local attractions like the dancing fountain at Plaza Salcedo and treating them to dinner at Calle Crisologo’s Bar Tech Restaurant. The evening before their departure, in a truly personal gesture, the former governor serenaded his guests with classic Filipino songs, including his favorites like “To All The Girls I’ve Loved Before,” “Maalaala Mo Kaya,” and “Dahil Sayo,” leaving them with cherished memories.
Governor Chavit’s defining trait is his unmatched generosity. Unlike

THE metro is bursting with events— concerts, exhibits, food fairs, and more. With so much happening, there’s hardly enough time to catch it all. Here are some suggested activities you can check out.
Unfold your forever
Now in its sixth edition, Conrad Manila brings back its signature bridal fair, Inspired Beginnings, on June 28 and 29, at the hotel’s Forbes and Taft Ballrooms. Co-presented by Getting Married Wedding Coordinators and Event Planners by Kutchie Zaldarriaga, the bridal fair features the most sought-after designers, stylists, and event professionals for a two-day celebration of wedding artistry, elegance, and inspiration.
“At Conrad Manila, we believe that weddings are more than just events—they are deeply personal and meaningful milestone celebrations that mark the beginning of a couple’s married journey. With Inspired Beginnings, we continue our tradition of curating only the finest for couples who seek an inspiring and memorable experience for the most important day of their lives,” said Conrad Manila general manager Fabio Berto. Highlights include: Devocion by Francis Libiran, a solo couture show unveiling his latest bridal collection, complemented by the exclusive designer trunk show where couples can try on bridal gowns and groom suits by Libiran; the Grand Finale Fashion Show, a multi-designer runway show directed by Robby Carmona and featuring designs by Rian Fernandez, Manny Halasan, Nat Manilag, Ehrran Montoya, Val Taguba, Vee Tan, and Ryan Ablaza Uson;


























many leaders, he openly shares his wealth, recently giving away P9 million during his June 21 birthday celebration, including P1 million each to winners from Luzon, Visayas, and Mindanao. He lives by the belief that “money isn’t yours until you spend it” and finds joy in helping others. Beyond public life, he is a devoted father who ensures his children are well supported. His playful warnings to

underperforming family members, quickly retracted with a smile, reveal the deep affection behind his lighthearted demeanor. His affection extends to his grandchildren, nieces, and nephews, all of whom affectionately call him “Papa” or “Papang,” rather than the more formal “Lolo” or “Grandpa.” His two-year-old youngest grandchild has even adopted the charming moniker “Manong Chavit.” Amused, the granddad cheekily recounts how the little one doesn’t stop there, completing his name with a flourish: “Manong Chavit Singson.” These endearing anecdotes paint a picture of a man who cherishes familial bonds above all else. As the former governor gracefully embraces the wisdom of age, he expresses a profound sense of contentment, feeling he couldn’t ask for more. His lifelong dedication to his beloved Ilocos Sur continues to bear fruit. A recent dream, meticulously nurtured for 15 years, has just been realized: the grand opening of the Chavit Coliseum, a testament to the collaborative efforts, especially of his brother, current Ilocos Sur Governor Jerry Singson. And another ambitious dream is on the horizon – the construction of a towering Jesus Christ statue, destined to be the tallest in the world, a beacon of faith and hope for generations to come. In the life of Chavit Singson, every day is an opportunity to connect, to give, and to inspire. He embodies a unique blend of power and humility, an enduring figure whose legacy will undoubtedly be defined by his boundless generosity, his infectious zest for life, and his unwavering commitment to making the lives of others brighter.

Art-inspired tablescapes, featuring tablescapes inspired by the works of Filipino masters and visual artists.
Blooms Events by Allen & JP pays tribute to Arturo Luz, while Ginger Gaddi channels the intricate artistry of Olivia D’Aboville Randy Lazaro draws inspiration from National Artist Hernando Ocampo, and Drew Menor reflects the romantic hues of National Artist Fernando Amorsolo



Dave Sandoval brings the vibrant energy of Mauro Malang, while Tiger Lim interprets the contemporary elegance of Lizanne Uychaco FJ Sionson embraces the surreal depth of Mark Justiniani, and Kathy Sy-King highlights the sculptural refinement of Impy Pilapil
Through these artistic inspirations, Inspired Beginnings 2025 honors Filipino creativity, ensuring every wedding setting is a fusion of beauty, culture, and vision. Get ‘devirginized’ at VLF XX: Hinog Now on its Encore Week, VLF XX: Hinog continues to put the spotlight on Filipino playwrights and has harvested stories and experiences
ripe for the picking.
Theater fans and lovers can still watch the 12 virgin plays and three revisited plays until June 29 at the Tanghalang Ignacio B. Gimenez (CCP Blackbox Theater), with matinee shows at 2:00 p.m. and gala shows at 8:00 p.m.

Celebrating its 20th year, the country’s theater festival of untried, untested, and unstaged one-act plays features five sets of three plays, with each following a central theme based on the different levels of ripeness: Bubot (Set A: Takbo, Batang Tondo by YOJ, Ang Bata Kag Ang Ilaga by Liane Carlo Suelam, Polar Coordinates by Ade Valenzona); Manibalang (Set B: Minating Ni Mariah Ang Manto Ng Mommy Ni Mama Mary by Eljay Castro Deldoc Unang Araw by Ivan Villacorta Gentolizo, Presidential Suite #2 by Siege Malvar); Kinalburo (Set C: Mga Magindara sa Siyudad by Chris Joseph Junio, Ang Problema sa Trolly by Imuthis, The Late Mister Real by Rolin Migyuel Obina); May Asim Pa (Set D: Anniversary by Nelsito Gomez, Don’t Meow for Me, Catriona by Ryan Machado Mommy G by Jobert Grey Landeza ); and Panghimagas (Set E/ Revisited: Identité by Jhudiel Claire Sosa, Pagkapit sa Hangin by Joshua Lim So,Sa
Babaeng Lahat by Elise Santos). Test your faith with ‘Grace’ Catch the restaging of the late playwright Floy Quintos’s final masterpiece, Grace , until June 29 at the PETA Theater in Quezon City. Directed by Dexter M. Santos, the play is based on the 1948 Marian apparitions in Lipa, Batangas. The story takes us through the journey of the visionary, Teresa. Many flocked to the site, witnessed rose petal showers, were healed of ailments, and renewed their faiths, but despite all these, the said apparitions did not receive official recognition from ecclesiastical authorities in 1951.
Bringing the story to life is the powerhouse ensemble, including Shamaine Centenera-Buencamino, Stella Cañete-Mendoza, Frances Makil-Ignacio, Matel Patayon, Marynor Madamesila, Raphne Catorce, Jojo Cayabyab, Reb Atadero, Dennis Marasigan, and Leo Rialp Experience opera with CCP’s ‘The Met: LIVE in HD’ Now in its 10th season, The Met: LIVE in HD , a special program by the Cultural Center of the Philippines (CCP), presents Wolfgang Amadeus Mozart’s Le Nozze di Figaro (The Marriage of Figaro) on July 1 at 5:30 p.m. at Glorietta 4, Cinema 1, in Makati City. This comedic opera centers on servants Figaro and Susanna, who are about to marry. The Count and Countess, each with personal reasons, hope to stop the wedding. While trouble lurks in the shadows, Figaro and Susanna juggle shocking truths with their immense love for each other.
Appreciating silent films
The International Silent Film Festival Manila returns this year with a rich tapestry of stories from across cultures and timelines, including Gigantes y Cabezudos (Spain), The Scent of Pheasant’s Eye (Japan), Wie Sich Der Kientopp Rächt, Aschenputtel, and Geschichten von Freiheit und Freundschaft (Germany), Beethoven (Austria), and Fra Diavolo (Italy).
The festival opens on July 11 with a special screening of Japan’s featured film, accompanied by Japanese silent film narrator Nanako Yamauchi, who will provide a live interpretation of the Japanese silent film. This aims to revive the traditional art of benshi (silent film narration) and offer audiences a rare and immersive cultural experience.
The festival runs from July 11 to 13 at Red Carpet Cinemas, ShangriLa Plaza, with a pocket screening event taking place on July 14 at Cine Adarna, UP Film Center. ISFFM 2025 promises not only a revival of the beloved silent film tradition but also a fresh encounter with its enduring power.
This year’s edition is presented by Instituto Cervantes, the Philippine Italian Association, Japan Foundation Manila, the Austrian Embassy, and the Goethe-Institut Philippinen.

WEDNESDAY,

NICKIE WANG,
ANGELICA VILLANUEVA, Writer
JASPER VALDEZ, Writer







By Nickie Wang
THE Center for International Trade Expositions and Missions (CITEM), the Department of Science and Technology–Philippine Textile Research Institute (DOST-PTRI), and the Philippine Fashion Coalition (PFC) have launched the FASHIONPhilippines Milan Mentorship Program 2025, a new initiative that aims to bring Filipino fashion designers, artisans, and textile technologists to the global stage.
The program will select 10 to 15 Filipino designers or brands to undergo intensive mentorship with local fashion experts and eight Europe-based mentors. It will culminate in a three-day curated showcase at the prestigious Fondazione Sozzani in Milan, Italy.
Central to the program is the use of Philippine Tropical Fabrics (PTFs) and other







textile fiber innovations developed by DOST-PTRI in collaboration with weaving communities and the agricultural sector. These sustainable materials— including abaca, pineapple, banana, bamboo, silk, and water hyacinth—will be featured in the collections to be presented in Milan, underlining the Philippines’ commitment to environmental sustainability and cultural preservation.
DOST-PTRI director Dr. Julius Leaño, Jr. said the initiative allows the Philippines to transform scientific breakthroughs into globally recognized fashion innovations, highlighting how agricultural byproducts can be converted into wearable designs. PFC chairman Carissa Cruz Evangelista described the program as a movement to establish the Philippines as a key player in sustainable, culturally rooted fashion by linking designers, weavers, and scientists.

The program also underscores the country’s rich

N O W & N E X T

and
supply of natural fibers and how they are being reimagined for contemporary use.
Abaca, woven by groups such as the B’laan, T’boli, and Bagobo into textiles like dagmay and t’nalak, is now being processed into yarn through new spinning technologies. Piña, traditionally crafted by the Aklanon community from red Spanish pineapple leaves, has gained international recognition and is now produced using waste pineapple leaves for blended yarns. Bamboo, typically used in construction, is being transformed into fibers through Bamboo Textile Fiber Innovation Hubs that provide livelihood opportunities in rural areas. Banana fibers from the plant’s pseudostem are used in both coarse and fine fabrics.




by language, geography, and queerness

WHAT does it mean to write from the margins when the margins are already overflowing with life, memory, and resistance?
In the case of Libulan II, a Binisaya queer anthology, it means writing without apology and in a language that has long been considered minor in both queer and literary conversations. Editors R. Joseph Dazo and Jessrel Gilbuena aren’t just collecting stories—they’re sustaining a fragile but insistent ecology of voices shaped by language, geography, and queerness. They aren’t asking permission to exist. They are claiming the page.
Dazo began writing fiction not with formal training or academic credentials but with a tally sheet from a jai-alai match and memories of teleseryes, radio dramas, and gossip.
“I am not a product of the academe,” he says, “but of a small community that loves to listen and exchange stories.”
That origin matters. It makes clear that literature does not only come from elite workshops or polished craft—it can come from the margins, and often does. In 2015, Bisaya Magasin—a publication that had been in existence since 1930—published its first queer short story, Dazo’s. That it took 85 years says more about the system than it does about the storytellers. Gilbuena’s journey likewise returns to the intimacy of language and land. Growing up on Bantayan Island, he at first wrote in English and Filipino, believing, as many of us were taught, that only these “major” languages carried literary legitimacy. College shifted that. He learned not only that he could write






DOST-PTRI’s CoBUILDTex program has expanded its application to eco-friendly indoor materials like acoustic panels and insulation. Water hyacinth, often seen as an invasive weed, is now a resource for textile production, thanks to a decorticating machine developed by the Institute. This not only turns waste into fiber but also creates livelihood options for marginalized communities. Philippine silk, under the SEDA Pilipinas program, is also being revived with the development of cocoon production hubs that strengthen the entire local silk value chain.
Supporting these fiber innovations is the Philippine NatDyes Center, which has identified over 100 plant-based dye sources and introduced natural dye powders, screen printing dyes, and digital inks. These advancements contribute to a more sustainable and biotechnologically driven future for color development in Philippine textiles. The FASHIONPhilippines Milan Mentorship Program is aligned with DOST-PTRI’s Textile Academy Program, a comprehensive initiative for building capacity in textile science and design. Filipino participants will not only receive worldclass design training but will also be grounded in sustainable technologies.
As part of the Milan showcase, visitors will be able to explore a dedicated exhibit of DOSTPTRI’s latest innovations, including natural textile fiber technologies, Philippine Tropical Fabrics, and handloom woven textiles.

in Cebuano and Sinantapihanon, but that he had to. The island demanded it. And so did his queer self.
“We wanted to show queer voices and experiences through a language that has less representation,” he says. Not lesser—just less represented.
Libulan II is not just an anthology. It is a counter-archive. It dares to place queer lives— untranslated, unassimilated—at the center of its gaze. It resists the hegemony of Filipino and English, yes, but also the narrow lens of Cebuano literature historically written by and for cis hetero men. It’s not about inclusion into dominant spaces. It’s about building spaces of our own. Both Dazo and Gilbuena are animated by refusal: to be erased, to be “improved,” to be deferred. Gilbuena continues writing in diaspora, holding on to his island even as he navigates life in the U.S. Dazo, meanwhile, is finishing a debut novel in Binisaya that chronicles queer life during the Duterte and Trump years—an effort he describes as both terrifying and necessary.
They know this work is difficult. Presses have turned them away. Institutions have ignored them. But they persist. They revise. They organize. They publish anyway. This is the labor of queer regional writers: not only to write but to make writing possible for others. Not only to tell stories but to insist that these stories matter—in the language we dream in, in the places we call home.
You may reach Chong Ardivilla at kartunistatonto@ gmail.com or chonggo.bsky.social